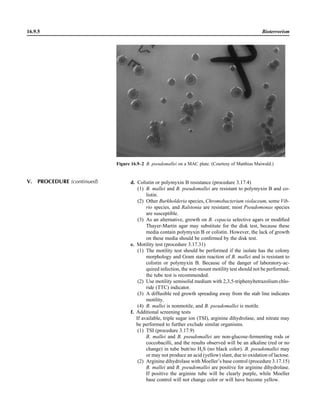
Microbiology handbook

This document provides a summary of the third edition of the Clinical Microbiology Procedures Handbook. It lists the editorial board members and contributors who assisted in developing the handbook. The handbook is split into three volumes that cover various topics related to clinical microbiology procedures, including bacteriology, mycology, parasitology, virology, immunology, and molecular diagnostics. It also includes sections on quality assurance, safety, epidemiology, and bioterrorism. The dedication is to Henry D. Isenberg, who pioneered the field of clinical microbiology and served as editor-in-chief for the original and second editions.



![Address editorial correspondence to ASM Press, 1752 N St., N.W., Washington, DC
20036-2904, USA
Send orders to ASM Press, P.O. Box 605, Herndon, VA 20172, USA
Phone: 800-546-2416; 703-661-1593
Fax: 703-661-1501
E-mail: books@asmusa.org
Online: http://estore.asm.org
Copyright ᭧ 2010 ASM Press
American Society for Microbiology
1752 N St., N.W.
Washington, DC 20036-2904
Library of Congress Cataloging-in-Publication Data
Clinical microbiology procedures handbook.—3rd ed. / editor in chief, third edition and
2007 update, Lynne S. Garcia.
p. ; cm.
“Editor in chief, original and second editions Henry D. Isenberg.”
Includes bibliographical references and index.
ISBN-13: 978-1-55581-527-1
ISBN-10: 1-55581-527-8
1. Diagnostic microbiology—Laboratory manuals. I. Garcia, Lynne Shore.
II. Isenberg, Henry D.
[DNLM: 1. Microbiological Techniques—methods—Laboratory Manuals.
WQ 25 C6415 2010]
QR67.C555 2010
616.9Ј041—dc22
2010014355
10 9 8 7 6 5 4 3 2 1
All rights reserved
Printed in the United States of America](https://image.slidesharecdn.com/microbiologyhandbook-150627125246-lva1-app6892/85/Microbiology-handbook-4-320.jpg)




























![1.1.1
1.1 Introduction
When the first edition of this handbook
was published, regulatory billing compli-
ance for laboratory tests was not a major
laboratory issue. Most hospital laborato-
ries generally performed services for their
own inpatients (and, occasionally, affili-
ated outpatients), and tests were billed ac-
cording to a formula established by the
business office. In the setting of prospec-
tive payment (e.g., diagnosis-related
groups), payment credit was allocated
based on a different formula. Today, how-
ever, microbiologists must be aware not
only of the scientific basis of infectious-
disease diagnostics but also of the costing,
coding, billing, and reimbursement for in-
dividual tests for patients seen in a broad
spectrum of health care settings with cov-
erage by an enormous number of health
care plans. Jargon previously unknown in
the clinical laboratory, such as reflex test-
ing, upcoding, downcoding, local cover-
age decision (LCD), and national cover-
age decision (NCD), is now so extensive
that a glossary of common terminology is
included in this section (Appendix 1.1–1).
The goal is to be reimbursed adequately
for all appropriate work performed in a
manner that is in compliance with all reg-
ulations.
The issues discussed in this section are
complex. In keeping with the mission of
this handbook, a model compliance pro-
cedure has been written. As with any pro-
cedure, we expect some customization to
occur. The model procedure deals primar-
ily with some of the more important reg-
ulatory principles. It should not, in any sit-
uation, take the place of guidance
established by your own compliance com-
mittee or of legal advice from your own
institution’s legal counsel. It simply rep-
resents a starting point for review of sa-
lient issues.
A brief historical overview of the eco-
nomic challenges faced by clinical micro-
biology laboratories is provided for back-
ground. This may be reviewed in detail in
the Institute of Medicine’s report Medi-
care Laboratory Payment Policy, Now
and in the Future (2). The history of re-
imbursement and compliance begins with
Title XVIII, commonly known as the So-
cial Security Act. This act outlines the
principles of the Medicare program, spec-
ifying broad benefit categories, including
physician and hospital services. In accor-
dance with section 1862 (a)(1)(A), the
Medicare program provides payment only
for diagnostic laboratory tests “that are
reasonable and necessary for the diagnosis
or treatment of illness or injury.” It does
not, however, authorize payment for
screening diagnostic services. Over the en-
suing 35 years since Title XVIII became
law, the interpretive determination of
whether a test meets the criteria of being
reasonable and necessary to justify pay-
ment by Medicare has become known as
“medical necessity.” Most other third-
party payers have established similar pay-
ment guidelines with which the laboratory
must be familiar. It is notable that both
Medicare and other payers may make spe-
cific exceptions to allow payment for
screening services (e.g., coverage of Pap
smears or prostate-specific antigen test-
ing). In the event that a coveragepolicydis-
allows payment for a service on the basisof
medical necessity, it is possible to transfer
financial liability to the patient providing
an advanced beneficiary notice (ABN) has
been properly executed which informs the
patient of their financial responsibility. In
2009, a laboratory-specific ABN, CMS-R-
131-L, was discontinued and replaced
with a generic ABN, CMS-R-131. Infor-
mation may be accessed at http://www.
cms.hhs.gov/BNI/02_ABN.asp.
The Social Security Act is known as a
statute, i.e., a piece of legislation voted
into law by Congress and signed by the
President. Statutes form the basis for sub-
sequent regulations that are rules estab-
lished by a federal agency in response to
its interpretation of a statute that it is its
duty to enforce. A number of federal agen-
cies are directly or indirectly involved
with laboratory reimbursement and com-
pliance. The CDC is responsible for the
scientific and quality aspects of laboratory
testing under the Clinical Laboratory Im-
provement Act (1967) and Clinical Labo-
ratory Improvement Amendment (CLIA)
(1988). The CDC is advised in this process
by the Clinical Laboratory Improvement
Advisory Committee. The Food and Drug
Administration (FDA) is responsible for
new product clearance and, since 2003, for
test complexity categorization under
CLIA. Medicare regulators have histori-
cally interpreted tests that are subject to
FDA approval or clearance but that have
not obtained, such as “not reasonable or
necessary” for payment purposes. The
FDA is assisted by its Microbiology Medi-
cal Device Advisory Committee. The
Centers for Medicare & Medicaid Ser-
vices (CMS), previously known as the
Health Care Financing Administration
(HCFA), administers the Medicare Pro-
gram. CMS interprets statutes and regu-
lations and issues these interpretations
through a variety of official documents
(e.g., The Medicare Program Integrity
Manual [1], program memoranda and
transmittals, and change requests) to de-
fine coverage criteria, establish national
limitation amounts, and establish national
coverage decisions (NCDs). CMS also
contracts with independent insurers
known generically as contractors and spe-
cifically as carriers (for part B outpatient
services), as fiscal intermediaries (FIs; for
part A inpatient services or part B services
through part A providers), and, more re-
cently, as Medicare administrative con-
tractors (MACs; for part A and part B ser-](https://image.slidesharecdn.com/microbiologyhandbook-150627125246-lva1-app6892/85/Microbiology-handbook-33-320.jpg)






![7. Development of a system for investigation and remediation of systemic prob-
lems and for dealing with business associates who are sanctioned
It is the responsibility of the employer to ensure that problems have been
corrected, repayments have been made, and all employees and business as-
sociates are not sanctioned by the Medicare program for previous illegal
activities.
B. Written procedures and policies
All procedures and policies should be developed under the direction of the CCO,
with formal review by the Compliance Committee. All documents should be in
written form and readily available to employees to whom the policies apply.
Additions and revisions should be clearly indicated and expediently commu-
nicated to employees, with documentation maintained.
1.2.2 Procedure Coding, Reimbursement, and Billing Compliance
III. WRITTEN PROCEDURES
AND POLICIES APPLICABLE TO
MICROBIOLOGY
A. Standards of conduct
All laboratory employees are expected to be honest in all their endeavors and
in compliance with all applicable regulatory requirements. Practices such as
sink testing (sending out results but not performing the work), issuing results
when controls are out of range (in conflict with the Clinical Laboratory Im-
provement Amendment [CLIA ’88]), and billing for work which is not ordered
or necessary are major areas of inappropriate practice which should not be
tolerated. In addition, no laboratory professional will induce anyone to send
laboratory work by offering kickbacks or inducements of any kind. This in-
cludes practices such as the provision of free work to clients or their families
or friends. No laboratory employee will induce any client to order a more ex-
pensive test if a less expensive one will suffice to make the clinical diagnosis,
nor will they encourage anyone to order a reflex or composite test(s) if not
medically necessary. No employee will suggest Current Procedural Terminol-
ogy (CPT) coding that systematically results in higher reimbursement, or Inter-
national Classification of Diseases, Clinical Modification (ICD-9-CM), coding
that will guarantee reimbursement if not medically appropriate. In general, if
any employee has to reflect on whether some action is legal or ethical, it is
probably best not to undertake that action. Referral of questionable issues to the
CCO or Compliance Committee is encouraged. It should be emphasized that a
dishonest or unethical practice renders an individual subject to immediate sanc-
tions. Sanctions may include oral or written warning, disciplinary probation,
suspension, demotion, dismissal from employment, or revocation of medical
staff privileges.
B. Medical-necessity issues
Medical necessity as defined by the Centers for Medicare and Medicaid Services
(CMS) is an assessment of whether the clinician’s reason for ordering a test is
covered (i.e., reimbursable) for the diagnosis or treatment of a specific illness
or injury. Examinations or diagnostic procedures performed in the absence of
signs or symptoms (often performed based on a patient’s age and/or family
history) are considered screening tests by the CMS and, with a few statutory
exceptions, are not reimbursed. The physician must provide a narrative diag-
nosis or diagnosis code (ICD-9-CM) so that Medicare or Medicaid and other
contractors can assess the claim for medical necessity as defined by national
coverage decisions (NCDs), local coverage decisions (LCDs), or other published
policies. Any ICD-9-CM code beginning with a “V” designates a screening
procedure and will therefore generally not be reimbursed.
1. Requisition design
a. The requisition should have orderable tests indicated by descriptor or
mnemonic consistent with the menu described in the current laboratory
II. ELEMENTS OF A
COMPREHENSIVE COMPLIANCE
PROGRAM (continued)](https://image.slidesharecdn.com/microbiologyhandbook-150627125246-lva1-app6892/85/Microbiology-handbook-40-320.jpg)


![formed. A hierarchy of analyte, specific method, generic method, and
unlisted should be followed in that order when assigning a code. Reflex
coding and composite coding should also be considered. Technical input
by a microbiologist is absolutely essential to correct coding.
b. CPT codes should be reviewed annually beginning with the new edition
published each October, with review complete by the end of the year, as
use for Medicare is mandatory beginning January 1.
c. Quarterly review of the Correct Coding Initiative edits should be per-
formed to ensure that mutually exclusive and column 1/column 2 code
edits will not result in denial and to determine code pairs where use of
modifier 95מ to override edits may be appropriate.
d. A careful cost analysis and charge review should accompany the CPT
review.
e. Revenue projection adjustments should be made based on the national
limitation amount for each test.
f. All documentation pertaining to the annual CPT review should be ap-
proved by the Compliance Committee.
g. Any changes in coding should be communicated to clients in the annual
notice, or anytime they are made on an interim basis.
2. ICD-9-CM selection
a. The ICD-9-CM is used to document the reason the physician ordered the
test.
b. Test requests should be accompanied by ICD-9-CM code(s).
c. A narrative diagnosis is acceptable and may be translated into a code by
a trained coder.
d. If the clinician does not supply an ICD-9-CM code, or if a narrative
cannot be accurately translated, the laboratory must obtain a diagnosis.
e. The ICD-9-CM code must be specific for a test and date of service. “Code
jamming” (arbitrarily inserting an ICD-9-CM code not meeting this con-
dition) is not acceptable.
f. Avoid “code steering” (the practice of suggesting use of a specific code[s]
that guarantees reimbursement or allows reimbursement for a screening
test).
3. Tests covered by claims
a. The laboratory should ensure that the client understands the specific test
by CPT code that is being ordered, performed, and billed (e.g., Chlamydia
direct fluorescent antibody, EIA, direct probe, amplified probe, or cul-
ture). The requisition and service manual should make this clear.
b. In the case of an ambiguous order (e.g., specimen-test mismatch or in-
sufficient information to assign a test and CPT code[s]), the laboratory
must contact the ordering provider to clarify the request.
c. In the case of a specimen and valid request received but not reported due
to technical issues, the laboratory must not submit a claim for service.
d. Modifiers must be used where appropriate to indicate special claims pro-
cessing conditions. In particular, modifier 95מ is used in microbiology
when replicates of the same CPT code are used on the same date of service
on unique specimens from different sources or to override Correct Coding
Initiative edits if allowed and testing is medically necessary.
4. Billing for calculations
Any calculations performed during the course of performing or determining
results of a test are not separately billable.
5. Reflex testing
a. Reflex testing is defined as testing that automatically occurs when an
initial test is outside normal parameters and indicates that a second related
test is medically appropriate and is considered a standard of care.
III. WRITTEN PROCEDURES
AND POLICIES APPLICABLE TO
MICROBIOLOGY (continued)
Procedure Coding, Reimbursement, and Billing Compliance 1.2.5](https://image.slidesharecdn.com/microbiologyhandbook-150627125246-lva1-app6892/85/Microbiology-handbook-43-320.jpg)









![Collection, Transport, and Manipulation of Clinical Specimens 2.1.3
Table 2.1–1 “Rule-out” clinical impressions and potential etiological agents
Clinical impression Potential etiological agent
Head and neck infections
Gingivitis Spirochetes, Prevotella intermedia, Prevotella oralis
Periodontitis Prevotella melaninogenica, spirochetes
Juvenile Actinobacillus actinomycetemcomitans
Early onset Spirochetes, Porphyromonas gingivalis, Actinobacillus actinomycetemcomitans
Adult Spirochetes, Prevotella melaninogenica, Actinobacillus actinomycetemcomitans
Progressive Bacteroides forsythus, Campylobacter rectus
Peritonsillar abscess (Quinsy) Polymicrobic: Streptococcus pyogenes, aerobic bacteria, plus normal microbiota of the oral cavity
Ludwig’s angina Viridans streptococci, peptostreptococci, Prevotella melaninogenica, Fusobacterium nucleatum
Pterygopalatine, infratemporal Anaerobes, aerobic and facultatively anaerobic gram-negative rods
Para- and retropharyngeal ab-
scesses, temporal fossa in-
fections
Polymicrobic with anaerobes, streptococci, staphylococci, Enterobacteriaceae
Septic jugular thrombophle-
bitis (postanginal sepsis)
Anaerobic streptococci, Prevotella spp., Porphyromonas spp., viridans streptococci, Streptococcus
pyogenes, Streptococcus pneumoniae, Eikenella corrodens
Suppurative parotitis Staphylococcus aureus, anaerobes, Enterobacteriaceae, Pseudomonas aeruginosa, oral microbiota,
Eikenella corrodens
Parotitis (viral) Mumps, coxsackievirus, influenza virus, parainfluenza virus types 1 and 3, lymphocytic choriomenin-
gitis virus, cytomegalovirus
Sinusitis Streptococcus pneumoniae, Haemophilus influenzae, Prevotella spp., Porphyromonas spp.,
Fusobacterium spp., Peptostreptococcus spp., Staphylococcus aureus, Veillonella spp.,
Streptococcus pyogenes, Moraxella catarrhalis, aerobic and facultatively anaerobic gram-negative
rods, microsporidia, free-living amebae, rhinovirus, influenza virus, parainfluenza virus, adenovirus
(children)
Cranial epidural abscess Peptostreptococcus spp., viridans streptococci, Streptococcus milleri group, Bacteroides spp.
(Prevotella spp.), Enterobacteriaceae, Pseudomonas aeruginosa, Staphylococcus aureus
Otitis media Streptococcus pneumoniae, Haemophilus influenzae, Moraxella catarrhalis, Streptococcus pyogenes,
Staphylococcus aureus, Pseudomonas aeruginosa
Chronic suppurative As above plus Staphylococcus epidermidis, Candida spp., Corynebacterium spp., Bacteroides spp.,
Peptostreptococcus spp.
Pharyngitis Streptococcus pyogenes, groups C and G beta-hemolytic streptococci (rare—Corynebacterium
diphtheriae, Corynebacterium ulcerans, Arcanobacterium haemolyticum, Neisseria gonorrhoeae,
mixed anaerobes [Vincent’s angina], Yersinia enterocolitica, Treponema pallidum), rhinovirus, co-
ronavirus, adenovirus, influenza viruses A and B, parainfluenza viruses (less common herpes sim-
plex virus [types 1 and 2], coxsackie A virus [types 2, 4, 5, 6, 8, and 10], Epstein-Barr virus,
cytomegalovirus, human immunodeficiency virus [HIV])
Laryngitis Moraxella catarrhalis, Bordetella pertussis, Bordetella parapertussis, Haemophilus influenzae (may
be secondary invaders), Mycobacterium tuberculosis, Corynebacterium diphtheriae (rare—also
Histoplasma capsulatum, Coccidioides immitis, Blastomyces dermatitidis, Candida spp.,
Treponema pallidum, herpes simplex virus, varicella virus), influenza virus, parainfluenza virus,
rhinovirus, adenovirus
Epiglottitis Haemophilus influenzae serogroup b, Haemophilus parainfluenzae, Streptococcus pneumoniae,
Staphylococcus aureus, Streptococcus spp., non-b Haemophilus influenzae, Pasteurella multocida
Tracheitis Staphylococcus aureus, Streptococcus pyogenes, Haemophilus influenzae b
Thyroiditis
Acute suppurative Oral microbiota, Staphylococcus spp., Streptococcus pneumoniae, anaerobes (needle aspiration); in
immunocompromised patients, Pseudoallescheria boydii, Candida spp., Aspergillus spp.,
Coccidioides immitis, Actinomyces spp.
Subacute granulomatous Mumps virus, rubeola virus, influenza virus, adenovirus, Epstein-Barr virus, coxsackievirus, cytomeg-
alovirus, Yersinia spp.
Common cold Ͼ200 different viruses, including different serotypes of adenoviruses, coronaviruses, influenza virus,
parainfluenza virus, respiratory syncytial virus, rhinovirus, and enterovirus
Pleuropulmonary infections
Acute community-acquired
pneumonia (adults)
Streptococcus pneumoniae, Haemophilus influenzae, Staphylococcus aureus, Legionella pneumophila,
Legionella spp., oral anaerobes (aspiration), Neisseria meningitidis, Moraxella catarrhalis,
Mycoplasma pneumoniae (very rare—Yersinia pestis, Bacillus anthracis, Francisella tularensis,
Pseudomonas pseudomallei), Histoplasma capsulatum, Blastomyces dermatitidis, Coccidioides
immitis, Actinomyces spp., Cryptococcus neoformans, Chlamydophila pneumoniae, Chlamydophila
psittaci, rubeola virus, varicella virus, influenza virus (A, B, C), adenovirus, Nocardia asteroides,
Sporothrix schenckii, Penicillium marneffei, Geotrichum spp., Histoplasma duboisii (rare)
(continued)](https://image.slidesharecdn.com/microbiologyhandbook-150627125246-lva1-app6892/85/Microbiology-handbook-53-320.jpg)



![Table 2.1–1 (continued)
Clinical impression Potential etiological agent
Fournier’s gangrene Escherichia coli, Pseudomonas aeruginosa, Proteus mirabilis, Enterococcus spp., Staphylococcus
spp., Peptostreptococcus spp., Bacteroides spp.
Abscess, cutaneous
Axilla, paronychia, breast,
hands, head, neck, and
trunk
Staphylococcus aureus, Staphylococcus epidermidis, Propionibacterium spp., Peptostreptococcus
spp., Leishmania tropica complex, Leishmania braziliense complex
Perineal, vulvovaginal,
scrotal, perianal, and but-
tocks
Staphylococcus aureus, Staphylococcus epidermidis, Propionibacterium spp., Peptostreptococcus
spp., Streptococcus spp.
Myositis
Bacterial Staphylococcus aureus, Streptococcus spp., influenza virus, coxsackievirus, Epstein-Barr virus, herpes
simplex virus type 2, parainfluenza virus type 3, adenovirus type 21, echovirus type 9
Protozoan Toxoplasma gondii, Trypanosoma spp., microsporidia
Tinea favosa Trichophyton schoenleinii (Trichophyton mentagrophytes, Trichophyton verrucosum, Microsporum
canis—rare)
Piedra
White Trichosporon beigelii (Indonesia, South America, Far East)
Black Piedraia hortae (tropical South America, Africa, Pacific Islands, Far East)
Tinea corporis (ringworm) Trichophyton spp., Microsporum spp., Epidermophyton spp.
Tinea imbricata Trichophyton rubrum, Trichophyton mentagrophytes, Epidermophyton floccosum
Onychomycosis
Dermatophytic Trichophyton rubrum, Trichophyton mentagrophytes (Epidermophyton spp., Microsporum spp.,
Scytalidium spp.—rare)
Nondermatophytic Candida albicans, Geotrichum candidium, Scopulariopsis brevicaulis, Cephalosparium spp.,
Acremonium spp.
Chromomycosis (dornato-
blastomycosis, dermatitis
verrucosa)
Phialophora verrucosa, Fonsecaea pedrosii, Fonsecaea computa, Cladiosporium carrionii,
Rhinocladiella aquaspersa, Botryomyces caespiosus, Exophiala spinifera, Exophiala jeanselmei
Viral skin infections Rubeola rubella virus, varicella virus, herpes simplex virus (types 1 and 2), herpes zoster virus, papil-
lomavirus (warts), parvovirus (erythema infectiosum), human herpesvirus 6-B (roseola); enteroviral
exanthems—hand-foot-mouth syndrome, coxsackievirus A (select types); other types of rashes—
echovirus and coxsackievirus, maculopapular; coxsackievirus and echovirus, petechial (caveat:
hard to differentiate from meningococcemia rash) (maculopapular rash—Marburg virus, Ebola vi-
rus, parapoxviruses [very rare])
Fungal and parasitic soft tis-
sue/skin infections
Dracunculus medinensis, Dirofilaria tenui, Dirofilaria ursi, Dirofilaria repens, Brugia spp. (lymph
nodes), Onchocerca volvulus, Madurella spp., Pseudoallescheria boydii, Scedosporium
apiospernum, Exophiala jeanselmei, Acremonium spp., Paracoccidioides brasiliensis,
Acanthamoeba spp.
Animal bites Acinetobacter spp., Actinobacillus actinomycetemcomitans, Bacteroides spp., Capnocytophaga spp.,
Corynebacterium spp., Eikenella corrodens, Enterococcus spp., Fusobacterium spp., Haemophilus
aphrophilus, Micrococcus luteus, Moraxella spp., Neisseria canis, Neisseria weaveri, Pasteurella
spp., Peptostreptococcus spp., Porphyromonas spp., Prevotella spp., Staphylococcus aureus,
Staphylococcus intermedius, Staphylococcus epidermidis, Streptococcus spp., Veillonella parvula
Burn wounds Acinetobacter baumannii, Enterobacter cloacae, Enterococcus faecalis, Escherichia coli, Klebsiella
pneumoniae, Pseudomonas aeruginosa, Staphylococcus aureus, Staphylococcus epidermidis
Trauma-associated wounds Anaerobes, Aspergillus spp., Enterobacteriaceae, Fusarium spp., Pseudomonas spp., Staphylococcus
spp., Streptococcus spp., zygomycetes, Acanthamoeba spp.
Bone and joint infections
Osteomyelitis
Hematogenous Staphylococcus aureus, Staphylococcus spp., Streptococcus agalactiae, Candida spp., Pseudomonas
aeruginosa, Salmonella serovars, Burkholderia pseudomallei, Echinococcus spp.
Trauma associated Streptococcus spp., Propionibacterium spp., Enterobacteriaceae, Pseudomonas spp., Staphylococcus
spp., anaerobic bacteria
Vascular insufficiency Enterobacteriaceae, anaerobic bacteria
Septic arthritis, nongonococ-
cal arthritis
Neisseria gonorrhoeae, Staphylococcus aureus, Streptococcus pyogenes, Streptococcus pneumoniae,
Streptococcus spp., Enterococcus spp., Enterobacteriaceae, obligately aerobic gram-negative rod-
shaped bacteria
(continued)
Collection, Transport, and Manipulation of Clinical Specimens 2.1.7](https://image.slidesharecdn.com/microbiologyhandbook-150627125246-lva1-app6892/85/Microbiology-handbook-57-320.jpg)
![Table 2.1–1 “Rule-out” clinical impressions and potential etiological agents (continued)
Clinical impression Potential etiological agent
Rare arthritides Brucella spp., Salmonella spp., rubella virus, mumps virus, coxsackievirus, echovirus (transient), par-
vovirus B19, hepatitis B virus (immune response), Mycobacterium spp., Legionella spp., Fusobac-
terium necrophorum
Infections of the eye
Eyelid Staphylococcus aureus, herpes simplex virus, varicella virus, papillomavirus, Trichophyton spp.,
Microsporum spp., Trichosporon spp.
Styes Staphylococcus aureus
Chalazion Staphylococcus aureus, Moraxella lacunata
Conjunctivitis
Purulent Neisseria gonorrhoeae, Neisseria meningitidis (newborn); Chlamydia trachomatis serovars D–K,
Staphylococcus aureus, Streptococcus pyogenes, Streptococcus pneumoniae, Haemophilus
influenzae (Haemophilus aegyptius), Pseudomonas aeruginosa, Escherichia coli, Moraxella spp.,
Corynebacterium diphtheriae, feline strains of Chlamydophila psittaci
Chronic Moraxella lacunata, Staphylococcus spp.
Parinaud’s oculoglandular Bartonella henselae (or possibly Afipia felis [both possibly agents of cat scratch disease]),
Lymphogranuloma venereum, Mycobacterium tuberculosis, Treponema pallidum, Haemophilus
ducreyi, Francisella tularensis, Epstein-Barr virus, mumps virus
Viral Adenovirus type 8, 19, or 37, usually causing keratoconjunctivitis severe disease types 8, 5, and 19;
serotypes 3, 7, and 4—pharyngoconjunctival fever; herpes simplex viruses, varicella-zoster virus,
Epstein-Barr virus, cytomegalovirus, rubeola virus, mumps virus, influenza virus, Newcastle dis-
ease virus (paramyxovirus)
Corneal infections
Bacterial keratitis Staphylococcus aureus, Staphylococcus spp., Streptococcus pneumoniae, Streptococcus spp.,
Pseudomonas aeruginosa, Bacillus cereus, Enterobacteriaceae, Neisseria spp., Moraxella
lacunata, Mycobacterium fortuitum, Mycobacterium chelonei, anaerobes
Fungal keratosis Fusarium solani, Candida albicans, Aspergillus fumigatus, Alternaria spp., Curvularia spp.,
Acremonium spp.
Viral keratosis Herpes simplex virus, varicella-zoster virus
Protozoan keratitis Acanthamoeba spp.
Lacrimal system infections
Dacryoadenitis Staphylococcus aureus, Streptococcus spp., Neisseria gonorrhoeae, Mycobacterium tuberculosis,
Treponema pallidum, mumps virus, Epstein-Barr virus
Canaliculitis Actinomyces israelii, Streptococcus spp., Candida spp., Aspergillus spp., herpes simplex virus,
varicella-zoster virus
Dacryocystitis Streptococcus pneumoniae, Staphylococcus aureus, Haemophilus influenzae, Pseudomonas
aeruginosa, Proteus mirabilis, Candida albicans, Aspergillus spp.
Retina and choroid infections Cytomegalovirus, Toxoplasma gondii
Endophthalmitis
Exogenous (surgical or
nonsurgical trauma)
Staphylococcus epidermidis, Staphylococcus aureus, Streptococcus spp., Bacillus spp., Pseudomonas
spp., Enterobacteriaceae, Haemophilus influenzae, Propionibacterium spp.
Endogenous Staphylococcus aureus, Neisseria meningitidis, Streptococcus spp., Bacillus cereus,
Enterobacteriaceae, Pseudomonas aeruginosa, Nocardia asteroides
Fungal (endogenous) Candida albicans, Aspergillus fumigatus, Aspergillus flavus
Fungal (exogenous) Candida spp., Aspergillus spp., Cephalosporium spp., Penicillium spp., Curvularia spp.
Orbital infections Staphylococcus aureus, Streptococcus spp., Peptostreptococcus spp., Pseudomonas aeruginosa,
Haemophilus influenzae, Mycobacterium spp., zygomycetes, Aspergillus spp., Echinococcus spp.,
Taenia solium
Nervous system infections
Acute bacterial meningitis Neisseria meningitidis, Streptococcus pneumoniae, Streptococcus agalactiae, Listeria monocytogenes,
Escherichia coli, Enterobacteriaceae, Leptospira spp., Haemophilus influenzae, Staphylococcus
aureus; less commonly, Peptostreptococcus spp., Fusobacterium necrophorum, Prevotella
melaninogenica, Bacteroides fragilis, Clostridium perfringens; rarely (zoonotic) Brucella spp.,
Francisella tularensis, Streptococcus suis, Yersinia pestis
Acute viral meningitis Coxsackievirus, echovirus, poliovirus, herpes simplex viruses 1 and 2, varicella-zoster virus, flavi-
viruses (St. Louis encephalitis), mumps virus, bunyaviruses (California group, La Crosse), rubeola
virus, lymphocytic choriomeningitis virus, adenoviruses
2.1.8 Specimen Collection, Transport, and Acceptability](https://image.slidesharecdn.com/microbiologyhandbook-150627125246-lva1-app6892/85/Microbiology-handbook-58-320.jpg)
![Table 2.1–1 (continued)
Clinical impression Potential etiological agent
Chronic meningitis Mycobacterium tuberculosis, Brucella spp., Francisella tularensis, Listeria monocytogenes (rare),
Neisseria meningitidis (rare), Tropheryma whipplei (rare), Borrelia burgdorferi, Leptospira spp.
(rare), Treponema pallidum, Actinomyces spp., Nocardia spp., Cryptococcus neoformans,
Coccidioides immitis (rare), Histoplasma capsulatum (rare), Candida spp., Aspergillus spp. (rare),
zygomycetes (rare), Parastrongyloides cantonensis, lymphocytic choriomeningitis virus, mumps
virus, herpes simplex virus, varicella-zoster virus, arbovirus, flavivirus, echovirus, parasites (rare),
Acanthamoeba spp.
Brain abscess Streptococcus spp., Peptostreptococcus spp., Porphyromonas spp., Bacteroides spp., Prevotella spp.,
Fusobacterium spp., Staphylococcus aureus, Enterobacteriaceae, Burkholderia cepacia,
Streptococcus pneumoniae, Neisseria meningitidis, Haemophilus influenzae, Listeria
monocytogenes, Haemophilus aphrophilus, Actinomyces spp., Nocardia spp., zygomycetes,
Mycobacterium spp., Naegleria spp. (primary meningoencephalitis), Acanthamoeba spp.,
Balamuthia mandrillaris (granulomatous encephalitis), Taenia solium
Spinal cord, peripheral and
cranial nerves
Poliomyelitis virus, herpesvirus simiae, human immunodeficiency virus type 1, human T-
lymphotrophic virus type 1; myelitis associated—cytomegalovirus, herpes simplex virus; following
infection with rubeola virus, varicella-zoster virus, influenza virus, mumps virus; Borrelia
burgdorferi, Borrelia recurrentis, Chlamydophila spp.
Epidural abscess Staphylococcus aureus, Escherichia coli, Pseudomonas aeruginosa, Streptococcus spp.,
Peptostreptococcus spp., Salmonella serovars, Staphylococcus spp., Nocardia spp., Actinomyces
spp., Fusobacterium spp., Mycobacterium spp., Aspergillus spp., Brucella spp., Treponema
pallidum
Shunt-associated infections Enterobacteriaceae, Enterococcus spp., Neisseria meningitidis, Propionibacterium acnes, Pseudomo-
nas spp., Staphylococcus aureus, Staphylococcus epidermidis, Staphylococcus warneri, Streptococ-
cus spp.
Ear infections
Otitis externa Staphylococcus aureus, Propionibacterium acnes, Pseudomonas aeruginosa
Otitis media Streptococcus pneumoniae, Haemophilus influenzae, Streptococcus pyogenes, Staphylococcus aureus,
Moraxella catarrhalis, Pseudomonas aeruginosa, Alloiococcus otitidis, respiratory syncytial virus,
influenza virus, enteroviruses, rhinoviruses, Chlamydia trachomatis (infants Ͻ6 months old)
(Corynebacterium diphtheriae, Mycobacterium tuberculosis, Mycobacterium chelonei, Clostridium
tetani, Ascaris lumbricoides—rare)
Encephalitides (7)
Viral
Mosquito borne Japanese encephalitis (JE), western equine encephalitis (WEE), eastern equine encephalitis (EEE), St.
Louis encephalitis (SLE), Murray Valley (MV) encephalitis (Australia), La Crosse, California, Ro-
cio encephalitis, Jamestown Canyon, snowshoe hare viruses
Tick borne Far-Eastern (Russian spring/summer), central European, louping ill, powassan (member of
Flaviviridae) viruses
EEE and WEE (Togaviridae), JE, Kunjin, MV encephalitis, SLE, and Rocio encephalitis viruses
(Flaviviridae), La Crosse, California, Jamestown Canyon, snowshoe hare viruses (Bunyaviridae)
Spongiform Creutzfeldt-Jakob, Creutzfeldt-Jakob variant bovine spongiform encephalitis—prions;
Paramyxoviridae (Hendra and Nipah viruses)
Meningoencephalitis Naegleria fowleri
Granulomatous encephalitis Acanthamoeba spp., Balamuthia mandrillaris
Infections caused by rather recently recognized etiological agents that may or may not be cultured
in routine microbiology laboratories
Bartonellosis Bartonella bacilliformis
Chromobacterium bacteremia Chromobacterium violaceum
Strawberry foot rot (exudative, scabbing dermatitis) Dermatophilus congolensis
Bacterial vaginosis Gardnerella vaginalis, Mobiluncus spp., Mycoplasma spp.
Legionellosis and related diseases Legionella spp.
Chronic nodular skin lesions (joint infections, wound infections) Prototheca spp.
Occasional endocarditis, dialysis Stomatococcus mucilaginosus
Rat bite fever (Haverhill fever) Streptobacillus moniliformis
Rat bite fever (Sodoku) Spirillum minus (Wright stain/dark field)
Cat scratch fever Bartonella henselae (Afipia felis)
Rhinosporidiosis Rhinosporidium seeberi (epithelial cell tissue culture)
Lobomycosis Loboa loboi (histological diagnosis)
Whipple’s disease Tropheryma whipplei
Erythema infectiosum (fifth disease) Parvovirus B19
Hemorrhagic fever Hantavirus (pulmonary and renal [outside northeast Asia])
Collection, Transport, and Manipulation of Clinical Specimens 2.1.9](https://image.slidesharecdn.com/microbiologyhandbook-150627125246-lva1-app6892/85/Microbiology-handbook-59-320.jpg)



























![3.1.1
3.1 Introduction to the Section
The Aerobic Bacteriology section of the
handbook has been reorganized to place
each part of the procedure together, in-
cluding collection, specimen processing,
supplies, QC, and the actual step-by-step
testing. This will allow the user to see an
overview of the entire procedure together.
When several different methods of testing
are acceptable, each option is presented.
The users should not reproduce the pro-
cedural text of this handbook in its entirety
but rather should choose among the vari-
ous options presented to produce practical
procedures applicable to their laboratory.
Procedures are first organized by ana-
tomic site. The user may wish to separate
each section of these procedures, as rec-
ommended in NCCLS document GP2-A4
(NCCLS is now known as the Clinical and
Laboratory Standards Institute [CLSI])
(9). For example, the information in Spec-
imen Collection can be used to provide a
separate nursing manual, the information
in Quality Control can be used for QC pro-
cedure, the information in Materials can
be used for an inventory for reagent prep-
aration and procurement of supplies, and
the information in the beginning of each
Procedure and many of the tables can be
used for a specimen inoculation manual
and a teaching manual for new employees,
etc. Flowcharts and tables within the Pro-
cedure can be used to prepare technical
bench manuals. References are provided
to allow the reader further information for
use in decision making when different op-
tions are being considered for test meth-
ods. Every attempt was made to provide
significant original reviewed articles to
support the recommended procedures. For
procedures 3.3.1 and 3.3.2, general text-
books are listed, which can be purchased
for reference material.
Often the laboratory is requested to
examine a specimen for only one micro-
organism. To avoid duplication, when a
procedure is presented for a specific or-
ganism, the procedure is listed following
the general procedure for the most com-
mon anatomic site of isolation of the or-
ganism. For example, the detection of
Neisseria gonorrhoeae is listed following
the genital culture procedure, although N.
gonorrhoeae may be sought in throat cul-
tures. The procedure for Brucella is found
following the general blood culture pro-
cedure, yet the organism can be found in
a variety of other sterile specimens, such
as joint and spinal fluid.
Following the procedures by anatomic
site are procedures for biochemical test-
ing in alphabetical order. The tests that
are listed are the generally accepted tests
that laboratories should be able to per-
form to identify the clinically important
microorganisms encountered in the labo-
ratory. Smaller laboratories may choose
to perform fewer tests and refer cultures
when less common microorganisms are
found in culture. Procedures for auto-
mated methods and multitest kits are not
presented because the list is extensive and
manufacturers provide updated package
inserts with the details for the perfor-
mance of their products and preparation
of laboratory procedure manuals for their
kits. However, tables comparing these
kits are presented to allow the user to
have information for decision making in
the purchase of such kits (also see refer-
ences 8 and 10). The biochemical tests
selected for inclusion in this handbook
emphasize those that are rapidly per-
formed. Consequently, the X and V factor
procedure is not listed, because laborato-
ries are encouraged to perform the more
rapid d-aminolevulinic acid test in com-
bination with growth on CHOC or the sat-
ellite test for Haemophilus influenzae. If
some media or biochemical tests are now
thought to be less sensitive than other
tests, the less sensitive media or tests are
not listed. For example, V agar is reported
to be less sensitive than human blood
Tween bilayer media (procedure 3.9.1)
for growth of Gardnerella vaginalis and
Burkholderia cepacia selective agar is
more sensitive than Pseudomonas cepa-
cia agar for B. cepacia (procedure
3.11.3). Thus, V agar and P. cepacia agar
are not listed as choices in the procedures.
Lastly, flowcharts are listed for com-
mon and important organisms. These
flowcharts are different from any you will
encounter, because they emphasize differ-
ent levels of identification for different an-
atomic sites and rely on the reported sen-
sitivities and specificities of each test for
decision on the need to confirm the results.
The flowcharts are designed to rapidly de-
tect clinically important microorganisms
with very few tests, but do not yield a spe-
cies level identification unless it would be
clinically relevant. The tables that follow
the flowcharts should help further in the
identification of both common organisms
and those that are of great clinical impor-
tance. Because partial DNA sequencing in
combination with phenotypic methods is
increasingly being used to identify com-
mon pathogens with unusual biochemical
reactions or fastidious or unusual patho-
gens, organism flowcharts and tables have
been updated in procedure 3.18 to include
reference to the recently published CLSI
guideline MM18-1A (2). For more exten-
sive identifications in cases of repeated
isolation of organisms that do not usually
initiate disease and for information on un-
usual organisms, the reader is referred to
other reference material (3–8, 11, 12).
I would like to thank the original au-
thors of the first edition for their phenom-
enal work from which the updated hand-
book was modeled and often duplicated in](https://image.slidesharecdn.com/microbiologyhandbook-150627125246-lva1-app6892/85/Microbiology-handbook-87-320.jpg)




![3.2.1.3 Aerobic Bacteriology
A N A L Y T I C A L C O N S I D E R A T I O N S
IV. QUALITY CONTROL A. Check appearance of reagents daily.
1. If crystal violet has precipitate or crystal sediment, refilter before use.
2. Change working solutions regularly if not depleted with normal use. Evap-
oration may alter effectiveness of reagents.
3. Limit reuse of working stain containers by discarding at least monthly.
ᮃ NOTE: Stains can become contaminated. When contamination is suspected,
use a new lot of stain.
B. Test laboratory staining procedure prior to use of new lots of each staining and
decolorizing reagent and at least weekly thereafter, using a gram-positive and
gram-negative microorganism. For laboratory staff that perform Gram stains
infrequently, it may be appropriate to have them test a positive and negative
control daily or even with each patient specimen tested.
1. Prepare a faintly turbid broth culture of Escherichia coli (ATCC 25922) and
Staphylococcus aureus (ATCC 25923).
2. Make slides using 2 drops per slide spread in the size of a dime.
3. Fix in methanol and store at 02מЊC.
4. Stain by laboratory Gram stain method.
5. Expected results
a. Gram-negative rods, pink
b. Gram-positive cocci, deep violet
6. Alternatively, with a broken applicator stick or toothpick, procure material
from between teeth and apply to the end of slide used for the specimen,
separating this area of the slide with a marker. This method provides a built-
in control with gram-positive and gram-negative representatives.
C. Take corrective action when stained smear preparations show evidence of poor
quality, stains are difficult to interpret, or interpretations are inaccurate. Poor
staining characteristics (e.g., faintly staining gram-positive organisms, retention
of crystal violet by gram-negative organisms, staining only of the edges of a
smear, precipitate on slide, etc.) may be due to specimen preparation, reagents,
or staining procedure. The following are some common causes of poor Gram
stain results.
1. Use of glass slides that have not been precleaned or degreased
2. Smear preparations that are too thick
3. Overheating of smears when heat fixation is used
4. Excessive rinsing during the staining procedure, especially if smear is not
properly fixed
5. Precipitate in reagents
D. Additionally, to ensure accuracy of interpretation, establish a system for re-
viewing Gram stain reports.
1. Review of selected Gram stains by supervisory personnel to determine train-
ing needs and aid in correlating relevant clinical information
2. Compare final culture results with Gram stain reports to check for recovery
of morphologies noted in the Gram stain but not recovered in the culture.
Similarly, review both the smear and the culture when organisms in 3 to 4ם
quantities are recovered in culture but not observed on the Gram stain.
ᮃ NOTE: An appreciable number of organisms discerned on a smear can
be cultivated. Discrepancies should be investigated for errors in smear eval-
uation or for indications for further culturing methods (e.g., anaerobic, fun-
gal, or acid-fast bacillus [AFB] culture).
3. Maintain a set of reference slides for competency training.
Include QC information on
reagent container and in
QC records.](https://image.slidesharecdn.com/microbiologyhandbook-150627125246-lva1-app6892/85/Microbiology-handbook-92-320.jpg)
















![b. Solution B: sodium bicarbonate, 5% (wt/vol)
sodium bicarbonate (NaHCO3),
reagent grade ..............................50 g
distilled water ............................1,000 ml
Dissolve in a glass bottle, label with a 1-year expiration date, and store at room
temperature.
2. Iodine (Kopeloff’s modification)
sodium hydroxide (NaOH),
reagent grade ............................... 4 g
distilled water ................................25 ml
iodine crystals (reagent grade) .............20 g
potassium iodide (reagent grade) ........... 1 g
distilled water .............................. 975 ml
Dissolve NaOH in 25 ml of distilled water in a brown glass bottle. Add iodine and
potassium iodide, and dissolve them well. Gradually add 975 ml of distilled water,
mixing well after each addition.
Caution: Iodine and potassium iodide are corrosive. Avoid inhalation, ingestion, and
skin contact.
3. Decolorizer: 3:7 acetone-alcohol
ethanol, 95% ............................... 700 ml
acetone (reagent grade) ................... 300 ml
Combine and mix in a brown glass bottle, label with a 1-year expiration date, and
store at room temperature.
Caution: Ethanol and acetone are flammable.
4. Safranin counterstain (Kopeloff’s)
safranin O, certified .........................20 g
ethanol, 95% ............................... 100 ml
distilled water ............................1,000 ml
In a 1,000-ml glass bottle, add only enough ethanol to the safranin to dissolve it
(approximately 50 ml). Add distilled water to safranin solution, label with a 1-year
expiration date, and store at room temperature. (Basic fuchsin, 0.8% [wt/vol], may
also be used for counterstain.)
Caution: Ethanol is flammable.
Gram Stain 3.2.1.20
APPENDIX 3.2.1–2 Rejection Criteria for Sputum and Endotracheal Aspirates for Culture
I. RATIONALE
Despite the frequency of lower respiratory tract infection, diagnostic studies to detect and
identify the etiologic agent are insensitive (8). Whether to perform a Gram stain or a
culture has been the topic of repeated studies with conflicting conclusions from profes-
sional societies, particularly for evaluating cases of community-acquired pneumonia (2,
3, 7). Part of the problem with the Gram stain is the variability of sampling for smears
and cultures (1, 6, 9). Everyone does agree that the culture of poorly collected respiratory
specimens is a wasteful use of laboratory resources and can lead to erroneous reporting
and treatment of patients (3, 5, 10). For laboratories that receive respiratory specimens
for smear and culture, the following generally accepted policy should be followed.
II. REJECTION CRITERIA
A. Do not reject sputum and endotracheal aspirates for culture for Legionella or AFB,
or specimens from cystic fibrosis patients.
B. Examine 20 to 40 fields from sputum smears under low power and endotracheal
smears under both low power and oil immersion using an 18- to 22-mm lens field of
view. Average the number of cells in representative fields that contain cells. Reject
the following for culture, as poorly collected or not consistent with a bacterial infec-
tious process.
1. Sputum: Ն10 SECs/LPF (3, 5, 10)
ᮃ NOTE: If the number of WBCs is 10 times the number of SECs and there is
3 to 4ם of a single morphotype of bacteria, accept the specimen for culture. Some
APPENDIX 3.2.1–1 (continued)](https://image.slidesharecdn.com/microbiologyhandbook-150627125246-lva1-app6892/85/Microbiology-handbook-109-320.jpg)




































![6. Use the following guidelines to report repeated isolation of the same organ-
ism.
a. Do not perform full identification and susceptibility testing on microor-
ganisms, if the patient has had a positive culture from the same source
within the last (x) days with what apparently is the same organisms(s)
and full identification and susceptibility testing were done on the previous
isolate(s).
ᮃ NOTE: For determination of (x) days, a good general rule is to repeat
identifications every 7 days, if the morphology is the same. An exception
would be for nonhemolytic staphylococci, all of which should be checked
with a coagulase test. Policies on how often to repeat antimicrobial sus-
ceptibility testing (AST) vary and should be based on evaluation of local
AST results and therapies used to treat disease. General guidelines include
7 days for oxacillin-susceptible staphylococci and most gram-negative
rods, 4 days for P. aeruginosa and selected other gram-negative rods, and
30 days for vancomycin-resistant enterococci. If extended-spectrum beta-
lactamases are present locally, additional susceptibility surveillance may
be indicated.
b. Ensure that the current organism is morphologically consistent with the
previous isolate(s) prior to reporting them as identical. Perform minimal
procedures to confirm the identification (oxidase, indole, catalase, etc.),
if possible.
c. Report the genus and species identification.
d. When referring identification to prior identification, indicate in the report
that the identification is “presumptive” followed by the following com-
ment after the organism name: “Refer to culture from [date] for complete
identification [and susceptibility testing].” Use caution so that referred
cultures are not referred to referred cultures.
e. If susceptibility testing was performed (e.g., not sure it is the same, pre-
vious positive overlooked, etc.), record these results but do not report
them, unless they differ from the prior result. Such reporting can distort
the data in the antibiogram produced by the laboratory for epidemiolog-
ical surveys.
7. Possible plate and broth contaminants
a. Review plates for possible plate contaminants (especially if the broth has
no growth) before reporting.
ᮃ NOTE: If a broth turns positive with a gram-positive organism after
the broth has been sampled, the organism may have been introduced at
the time of sampling.
b. Do not report clear contaminants (those not on the streak).
c. For questionable contaminants, add the following notation to the report:
“[Organism name] present in culture, cannot distinguish true infection
from plate contamination; consider confirmation of isolate with appro-
priate follow-up culture.”
d. Investigate repeated isolation of the same mold or skin microbiota, and
perform cleaning of laboratory equipment to prevent recurrence. Special
attention should be paid to the potential pathogenicity of a “contaminant”
isolated repeatedly from the same or different anatomic sites.
C. Reporting mixed cultures
1. When three or more microorganisms of questionable clinical significance are
isolated, report as a mixed culture.
Example: “Culture yields abundant growth of Ͼ3 colony types of enteric
gram-negative bacilli. Please consult microbiology laboratory if
more definitive studies are clinically indicated.”
3.3.2.12 Aerobic Bacteriology
VI. REPORTING RESULTS
(continued)](https://image.slidesharecdn.com/microbiologyhandbook-150627125246-lva1-app6892/85/Microbiology-handbook-146-320.jpg)
![Bacterial Growth on Primary Culture Media 3.3.2.13
VII. INTERPRETATION A. Report culture results with emphasis on the clinical importance and relevance
to the diagnosis and treatment of the patient.
B. Reporting normal microbiota, mixed cultures, or questionable contamination
with the same level of detail as done for clinically significant pathogens can
lead to erroneous diagnoses and treatment of the patient.
C. Use the Gram stain of the specimen as a guide to interpretation of results.
D. Bacterial cultures from normally sterile sites typically contain a low number of
organisms so that recovery of isolates from these types of specimens may be
difficult to achieve. The primary specimen Gram stain should be compared to
the morphotypes recovered from culture. Anaerobes or fastidious bacteria may
be present if an organism is seen in the direct Gram stain but is not recovered
on aerobic culture. Other methods may need to be used to isolate the agent,
including incubation of cultures under different atmospheric conditions, the use
of specialized media and stains, and the use of DNA probes and immunological
tests.
2. If only normal microbiota is observed, report as the following.
a. Gastrointestinal
b. Skin
c. Genital
d. Oral-nasal
e. Staphylococcal skin (for wounds with only coagulase-negative staphy-
lococci in adults)
ᮃ NOTE: Reporting coagulase-negative staphylococci may be indicated
for cluster epidemics in neonatal units or intensive care units)
f. Mixed anaerobic microbiota
g. Mixed gram-positive microbiota, NOS (for mixed respiratory microbiota
[staphylococci, diphtheroids, and enterococci] without viridans group
streptococci)
h. Alternatively, report as “No significant microorganisms isolated.”
D. If no growth is observed on all media, send out report as “No growth in x days,”
where “x” is the number of days the culture has been incubated.
1. When the culture has been incubated the number of days required based on
the source, document that the culture report is final.
2. If incubation is continued beyond the final date but no more reports will be
issued unless it turns positive, add the comment “Cultures will be held for
days.”
E. Telephone clinically or epidemiologically critical results to the appropriate per-
sons. Such results include the following.
1. Anything isolated from normally sterile source (blood, CSF, peritoneal fluid,
tissue, etc.)
2. Pathogens of serious clinical or epidemiologic concern, for example, Neis-
seria gonorrhoeae, Streptococcus pyogenes, Clostridium difficile toxin, en-
teric pathogens, and Mycobacterium tuberculosis
3. Take the initiative to immediately call any unusual, impressive finding that
is of critical importance to patient care.
F. Document all testing on a hard copy or computerized work record.
G. Document reference laboratory identification when performed by reporting
“Identification confirmed by” followed by reference laboratory name and ad-
dress.
H. Document all processing and reporting errors in the report, and telephone report
of such errors to the person who ordered the test.
VI. REPORTING RESULTS
(continued)](https://image.slidesharecdn.com/microbiologyhandbook-150627125246-lva1-app6892/85/Microbiology-handbook-147-320.jpg)




![c. Allow the iodine to dry (about a minute), and avoid touching the site.
ᮃ NOTE: If povidone-iodine is used, it must be allowed to dry com-
pletely (about 2 min); 2% chlorhexidine gluconate in isopropyl alcohol
may be used in place of tincture of iodine.
d. For pediatric patients, omit the iodine step and clean two additional times
with separate preparation pads saturated with 70% isopropyl alcohol or
ethyl alcohol (26).
3. Prepare the septum of the blood culture bottle and the rubber stoppers on
bottles or tubes. Label the bottles with the patient name and the date and
time of draw. Site of draw may also be listed.
4. Vigorously wipe septa with 70% alcohol and allow to dry completely, usu-
ally for 30 to 60 s.
ᮃ NOTE: Wiping the septum with iodine is usually unnecessary but may
be considered if there is a history of problems with Bacillus spores or mold
contamination.
5. While wearing gloves, insert the needle into the vein and withdraw the blood.
Use a new needle if the first attempt is not successful. Do not repalpate the
skin after it is disinfected.
6. Apply a safety device to protect the phlebotomist from needle exposure.
ᮃ NOTE: Safety devices consist of domes with internal needles that attach
either to a syringe or directly to the tubing used in collecting the blood. The
external port of these devices will accommodate a syringe or the end of a
butterfly needle depending on the product (e.g., blood transfer device [cat-
alog no. 364880; Becton Dickinson and Co., Paramus, NJ], BacT/Alert blood
transfer device [bioMe´rieux Inc., Hazelwood, MO], Angel Wing adapter
[Sherwood Davis & Geck, St. Louis, MO]).
7. Inoculate first the aerobic bottle and then the anaerobic bottle with no more
than the manufacturer’s recommended amount of blood.
a. For direct inoculation into the bottles from the needle apparatus, mark
the side of the bottle with the manufacturer’s recommended draw.
b. If using a needle and syringe, use the volume markings on the syringe to
note the volume. Hold the syringe plunger during transfer to avoid trans-
fer of excess blood into bottles having a significant vacuum.
ᮃ NOTE: There is no need to change the safety device between bottle in-
oculations (22).
8. Thoroughly mix bottles to avoid clotting.
9. After phlebotomy, dispose of needles in sharps container and remove resid-
ual tincture of iodine from the patient’s skin by cleansing with alcohol to
avoid development of irritation.
F. Collection of blood from intravascular catheters
ᮃ NOTE: Using either quantitative cultures (Appendix 3.4.1–2) or time to posi-
tive signal of cultures processed on an automated instrument, the comparison
of cultures that are drawn through an indwelling intravenous catheter and
through a peripheral site may be useful for diagnosis of catheter-related sepsis
(2).
1. Label bottles with patient name, site of draw, and date and time of draw.
2. Disinfect the septum of the blood culture bottle and the rubber stoppers on
bottles or tubes with 70% alcohol as for peripheral draw. Allow to dry com-
pletely, usually for 30 to 60 s.
3. Using two separate alcohol preps, scrub catheter hub connection for 15 s
with 70% alcohol. Air dry.
3.4.1.3 Aerobic Bacteriology
II. SPECIMEN COLLECTION,
TRANSPORT, AND HANDLING
(continued)](https://image.slidesharecdn.com/microbiologyhandbook-150627125246-lva1-app6892/85/Microbiology-handbook-152-320.jpg)

![3. Alternatives to automated systems
a. Broth media in bottles to be ob-
served manually (TSB, supple-
mented peptone, THIO, anaero-
bic BHI)
b. Biphasic media (agar and broth
in one bottle)
(1) BBL Septi-Chek (BD Mi-
crobiology Systems)
(a) Agar consists of
CHOC, MAC, and
malt agar.
(b) Broth options are
BHI, BHI supple-
mented, TSB, TSB
with sucrose, Colum-
bia, THIO, and
Schaedler broth.
(2) PML biphasic (PML Mi-
crobiologicals, Inc.)
(a) Agar consists of
CHOC and BHI agar.
(b) Broth is TSB.
c. Lysis-centrifugation system of
ISOLATOR (Wampole Labo-
ratories)
B. Reagents and media for biochemical
tests
1. Agar plate media listed in Table
3.3.1–1
2. Gram stain reagents
3. Antimicrobial susceptibility test-
ing (AST) system and beta-lacta-
mase test (refer to section 5)
4. d-Aminolevulinic acid (ALA) re-
agent (procedure 3.17.3)
5. Bile-esculin slants (procedure
3.17.5)
6. 10% Bile (sodium desoxycholate
[procedure 3.17.6])
7. Catalase test reagent (procedure
3.17.10)
8. Coagulase rabbit plasma and (op-
tionally) staphylococcal aggluti-
nation tests (procedures 3.17.13
and 3.17.14)
9. Disks (procedure 3.17.4)
a. 10 U of penicillin
b. 30 lg of vancomycin
c. 1 lg of oxacillin
d. Optochin (procedure 3.17.38)
e. 300 U of polymyxin B or 10
lg of colistin
3.4.1.5 Aerobic Bacteriology
10. Spot indole reagent (procedure
3.17.23)
11. Broth for motility (procedure
3.17.31)
12. Ornithine decarboxylase (proce-
dure 3.17.15)
13. Oxidase test reagent (procedure
3.17.39).
14. L-Pyrrolidonyl-b-naphthylamide
(PYR) substrate and developer
(procedure 3.17.41)
15. Multitest gram-negative and
gram-positive commercial auto-
mated, semiautomated, and man-
ual kit identification systems, re-
ferred to as “kits.” For detailed
information on these products, re-
fer to Evangelista et al. (9).
16. Media for identification of yeast
and mold (see section 8)
a. CHROMagar (optional)
b. Calf serum for germ tube
c. India ink
d. Phenol oxidase test (caffeic
acid disk or birdseed agar)
e. Rapid trehalose test (section 8)
f. Urea agar (procedure 3.17.48)
17. Other media as needed for special
identifications
a. Acridine orange stain (proce-
dure 3.2.2)
b. Media for H2S detection (pro-
cedure 3.17.22)
c. Quellung test (procedure
3.17.42)
d. Leucine aminopeptidase
(LAP) (procedure 3.17.26)
e. Salt (6.5%) broth (procedure
3.17.43)
f. Optional: serologic reagents
for grouping Salmonella and
Shigella (Appendix 3.8.1–1) or
grouping beta-hemolytic strep-
tococci into the Lancefield
groups (procedure 3.11.8)
g. Rapid urea disk (procedure
3.17.48)
C. Supplies
1. 3-ml syringes with safety apparatus
or venting needle
2. Alcohol (70 to 95%) and gauze
3. Microscope slides
III. MATERIALS (continued)](https://image.slidesharecdn.com/microbiologyhandbook-150627125246-lva1-app6892/85/Microbiology-handbook-154-320.jpg)
![Blood Cultures—General Detection and Interpretation 3.4.1.6
A N A L Y T I C A L C O N S I D E R A T I O N S
IV. QUALITY CONTROL A. Verify that plate media meet expiration date and QC parameters per current
Clinical and Laboratory Standards Institute (CLSI; formerly NCCLS) document
M22. See procedures 14.2 and 3.3.1 for further procedures.
B. See individual tests in procedure 3.17 for biochemical test QC.
C. Blood culture bottles
1. For in-house-prepared culture media, verify that each lot of media will sup-
port the growth of bacteria likely to be present in blood cultures, including,
but not limited to, the following microorganisms (as listed in Table 2 of
CLSI document M22-A3 [4]).
a. Aerobic bottles
(1) Pseudomonas aeruginosa (ATCC 27853)
(2) Streptococcus pneumoniae (ATCC 6305)
b. Anaerobic bottles
(1) Bacteroides fragilis (ATCC 25285)
(2) S. pneumoniae (ATCC 6305)
c. Method of testing
(1) Prepare a broth culture of each microorganism equivalent to a 0.5
McFarland standard.
(2) Inoculate each bottle with 0.01 ml (10 ll) of suspension.
(3) Incubate for up to 5 days and observe for visible growth.
2. Maintain records provided by manufacturers of commercial blood culture
systems, documenting their QC testing.
ᮃ NOTE: Regulatory agencies do not require routine QC checks by the user
of commercially purchased blood culture bottles.
D. Check CHOC on biphasic medium paddles for growth of Haemophilus influ-
enzae and Neisseria gonorrhoeae.
E. Prior to institution of a blood culture system, determine that it will support the
growth of a variety of microorganisms, including fastidious gram-negative rods
and cocci. Use bottles supplemented with human blood from volunteers for
testing fastidious microorganisms.
F. Contamination
1. Have a system in place to determine if a culture has been collected from an
intravascular catheter and whether a peripheral collection accompanied the
line collection for adults. Educate clinicians on the need to collect both, to
properly evaluate the culture results (2, 26).
2. Monitor positive blood culture results regularly for skin contamination.
a. For purposes of determination of contamination rate, consider only skin
contaminants from venipuncture as significant. These consist of the fol-
lowing.
(1) Coagulase-negative staphylococci (excluding pediatric and line col-
lections)
(2) Bacillus species
(3) Corynebacterium species
(4) Propionibacterium species
b. Exclude positive cultures as skin contaminants if more than one blood
culture from the same patient is positive for any of the microorganisms
listed above, provided that for coagulase-negative staphylococci the an-
tibiograms are consistent with the isolates being the same strain.
c. Include as skin contaminants all positive cultures, even if both bottles are
positive or only one culture was collected (20).
d. Calculate the contamination rate by dividing the number of cultures con-
taining skin contaminants by the total number of cultures collected by
venipuncture.
Include QC information on
reagent container and in
QC records.](https://image.slidesharecdn.com/microbiologyhandbook-150627125246-lva1-app6892/85/Microbiology-handbook-155-320.jpg)







![Blood Cultures—General Detection and Interpretation 3.4.1.14
VII. INTERPRETATION A. The report of a positive culture generally means that the patient is bacteremic.
However, skin microbiota may contaminate the culture, causing a false-positive
result or pseudobacteremia. Pseudobacteremias have many other causes.
1. If organisms are seen but not cultured, dead organisms can be found in the
medium components and produce a positive smear.
2. Bacillus or other bacteria can be present on the nonsterile gloves of the
phlebotomist (34).
3. Laboratory contamination of equipment or supplies used in culture may con-
taminate the patient specimens.
P O S T A N A L Y T I C A L C O N S I D E R A T I O N S
VI. REPORTING RESULTS A. For “No growth cultures,” indicate the length of incubation: “No growth after
x days of incubation” for both preliminary and final reports.
B. Positive cultures
1. Immediately report Gram stain results of all positive cultures, or additional
organisms found in previously positive cultures, to the physician of record,
with as much interpretive information as possible (using Table 3.4.1–2 for
guidelines).
2. Follow immediately with a written or computer-generated report including
the following.
a. Number of positive cultures compared with total number of specimens
collected for specific patient.
ᮃ NOTE: There is no justification for telling the physician that one or
both bottles in the set are positive, because the number of positive bottles
in a set does not reliably differentiate contamination from true infection
(20).
b. Date and time of collection and receipt
c. Date and time positive result is reported and whether it was from a catheter
draw or a peripheral draw.
ᮃ NOTE: Such information is useful in the diagnosis of catheter-related
sepsis (2).
d. Name, phone number, and location of person taking report
Example: Positive culture reported to Dr. X on 07/01/09 at 1300 h.
3. For single positive cultures with microorganisms generally considered skin
contaminants (coagulase-negative staphylococci, viridans group strepto-
cocci, corynebacteria, Propionibacterium [30]), perform only minimal iden-
tification and do not perform AST. For single positive cultures with these
potential skin contaminants (30), report result with a comment similar to the
following: “One set of two positive. Isolation does not necessarily mean
infection. No susceptibility tests performed. Contact laboratory for further
information.”
4. Provide genus and species identification as soon as possible, using tests in
Table 3.3.2–5 and charts in procedures 3.18.1 and 3.18.2.
5. For subsequent positive cultures, it is not necessary to repeat biochemical
testing if the microorganism has the same Gram and colony morphology as
the first isolate. Perform a few spot tests (catalase, coagulase, indole, PYR,
etc.) to verify that it is the same strain. Report as “Probable [genus and
species]; refer to prior positive for complete identification and susceptibility
testing.”](https://image.slidesharecdn.com/microbiologyhandbook-150627125246-lva1-app6892/85/Microbiology-handbook-163-320.jpg)






![3.4.2.1
3.4.2 Brucella Cultures
P R E A N A L Y T I C A L C O N S I D E R A T I O N S
I. PRINCIPLE
Brucella is a fastidious, aerobic, small,
gram-negative coccobacillus that is slow
growing and difficult to isolate. It is zoo-
notic, with four species being recognized
as causing infection in humans: Brucella
abortus (cattle), Brucella melitensis
(goats, sheep, and camels), Brucella suis
(pigs), and Brucella canis (dogs). Al-
though species identification is of interest,
it is not clinically important and is diffi-
cult to perform. Key characteristics of the
species can be found in reference 9.
Infections are seen in essentially two
patient populations. The first group is in-
dividuals who work with animals and who
have not been vaccinated against brucel-
losis. This patient population includes
farmers, veterinarians, and slaughterhouse
workers. B. abortus and B. suis are the
agents most likely to cause infections in
this group of individuals. They become in-
fected either by direct contact or by aero-
sol from infected animal tissues.
Brucellosis is also seen in individuals
who ingest unpasteurized dairy products
contaminated with brucellae. This is most
likely to occur in individuals who travel to
or migrate from rural areas of Latin Amer-
ican and the Middle East where disease is
endemic in dairy animals, particularly
goats and camels. B. melitensis is the most
common agent seen in this patient popu-
lation. Brucellae are included in the mi-
croorganisms at risk for being used in a
bioterrorist event; refer to procedure 16.6
for further information on this agent’s role
in bioterrorism.
II. SPECIMEN COLLECTION,
TRANSPORT, AND HANDLING
A. Aseptically collect blood or bone marrow (from the iliac crest [8]) during a
fever episode.
B. Refer to procedure 3.4.1 for collection. Place specimen immediately in blood
culture bottles.
ᮃ NOTE: CSF, lymph nodes, joint fluid, and liver or spleen biopsy specimens
may be positive for Brucella, which will be detected by routine culture of these
specimens. Follow this procedure to confirm the identification.
III. MATERIALS A. Media
1. Primary media
a. Biphasic blood culture
(1) Septi-Chek (CHOC, MAC,
and malt agar with BHI or
Columbia broth) (BD Di-
agnostic Systems)
(2) PML biphasic media
(CHOC and BHI agar with
TSB) (PML Microbiologi-
cals, Inc.)
(3) Castaneda bottles (TSB or
brucella broth and agar)
(2)
b. Automated blood culture system
ᮃ NOTE: Automated systems
may require subculture to detect
growth. The pediatric lysis-cen-
trifugation method using a vol-
ume of 1.5 ml was not as sen-
sitive as automated methods in
one study (15).
2. Media for blind subculture or for
positive cultures
a. BAP preferably with BHI base
b. CHOC
c. Brucella agar
It is imperative that these
cultures be handled in a
biological safety cabinet.](https://image.slidesharecdn.com/microbiologyhandbook-150627125246-lva1-app6892/85/Microbiology-handbook-170-320.jpg)







![B. In cases of Oroya fever, collect thick and thin blood smears (preferably before
antimicrobial therapy) from fresh drops of peripheral blood for staining with
Wright or Giemsa stain (procedure 9.8.6 or 9.8.5, respectively).
C. Collect 10 ml of blood for culture into an ISOLATOR tube using sterile tech-
nique (see Appendix 3.4.1–2). Prior antimicrobial treatment negates the ability
to culture the organism. Collection of more than one specimen may increase the
yield of a culture.
ᮃ NOTE: Automated blood culture systems have yielded Bartonella, but the
organism typically does not produce sufficient CO2 to be detected by the in-
strument. On day 8, remove a small aliquot of blood culture broth and stain
with acridine orange (procedure 3.2.2) or observe motile organisms by wet
mount using phase-contrast microscopy. If growth is observed, subculture to
CHOC (14). La Scola and Raoult successfully cultured 1 ml of blood collected
into a Vacutainer tube containing lithium heparin (Becton Dickinson Systems,
Rutherford, NJ) and plated it onto Columbia sheep blood agar (10). The ISO-
LATOR method in combination with rabbit blood agar has the best yield for
most species (5, 8).
3.4.3.2 Aerobic Bacteriology
III. MATERIALS A. ISOLATOR system (Appendix
3.4.1–2)
B. Anaerobic jar or bag and CO2-gen-
erating system
C. Sterile M199 tissue culture medium
(Gibco, Invitrogen, Carlsbad, CA)
for dilutions
D. Media
1. Fresh CHOC (double poured [40
ml per plate] and less than 3 weeks
old has higher yield)
2. Heart infusion agar with 5% rabbit
blood
3. In addition to the media listed
above, the following media have
been used successfully for culture
of B. bacilliformis.
a. Columbia agar with 10% whole
horse, rabbit, or sheep blood (2,
3)
b. Biphasic media consisting of the
following
(1) A solid medium of 10% de-
fibrinated sheep blood, glu-
cose, tryptose, NaCl, and
agar
(2) A liquid RPMI 1640 me-
dium (Mediatech, Fisher
Scientific) enriched with
HEPES buffer, sodium bi-
carbonate, and 10% fetal
bovine serum (9)
ᮃ NOTE: In some cases successful
culture of Bartonella can only be
achieved by initial cultivation in an en-
dothelial tissue culture cell line or in
liquid RPMI 1640 medium (2).
A N A L Y T I C A L C O N S I D E R A T I O N S
IV. QUALITY CONTROL A. Test each medium with a known Bartonella species (e.g., B. henselae ATCC
49793, B. quintana ATCC 51694, B. bacilliformis ATCC 35685 or ATCC
35686) to verify the ability to grow the organism.
B. Check each medium for sterility by incubation of sample plates and animal
blood products prior to culture.
C. Refer to procedure 3.3.1 for other QC requirements.
II. SPECIMENS (continued)
Include QC information on
reagent container and in
QC records.](https://image.slidesharecdn.com/microbiologyhandbook-150627125246-lva1-app6892/85/Microbiology-handbook-178-320.jpg)





![C. Specimen collection: body fluid specimens collected by percutaneous aspiration
for pleural, pericardial, peritoneal, amniotic, and synovial fluids
ᮃ NOTE: Refer to procedure 3.3.1 for additional details. The following can be
copied for preparation of a specimen collection instruction manual for physi-
cians and other caregivers. It is the responsibility of the laboratory director or
designee to educate physicians and caregivers on proper specimen collection.
Use care to avoid contamination with commensal microbiota.
1. Clean the needle puncture site with alcohol, and disinfect it with an iodine
solution (1 to 2% tincture of iodine or a 10% solution of povidone-iodine
[1% free iodine]) to prevent introduction of specimen contamination or in-
fection of patient. (If tincture of iodine is used, remove with 70% ethanol
after the procedure to avoid burn.)
2. Aseptically perform percutaneous aspiration with syringe and needle to ob-
tain pleural, pericardial, peritoneal, or synovial fluid. Use safety devices to
protect from needle exposure.
3. Immediately place a portion of the joint fluid or peritoneal fluid collected
from patients with CAPD or SBP into aerobic and anaerobic blood culture
bottles, retaining some (0.5 ml) in syringe for Gram stain and direct plating.
a. Use the minimum and maximum volumes recommended by the bottle
manufacturer (generally up to 10 ml is the maximum for each bottle).
b. Alternatively, inoculate the blood culture bottles after receipt in the lab-
oratory.
4. Submit other fluids and the remainder of specimens placed in blood culture
bottles in one of the following
a. A sterile, gassed-out tube or a sterile blood collection tube without pre-
servative (e.g., sterile Vacutainer brand red-top tube); however, fluids in
such tubes may clot during transport. Alternatively, fluids may be placed
in a purple-top tube containing an anticoagulant such as heparin or SPS,
although some fastidious organisms may be inhibited if the specimen is
delayed in transport. EDTA and citrate anticoagulants are the most likely
to inhibit microorganisms in fluid specimens and should not be used.
b. Anaerobic transport vial (for small-volume specimens)
c. Specimens received by the laboratory in a syringe with the needle still
attached should be rejected because of the risk of a needless sharps ex-
posure by laboratory staff. The physician should be immediately phoned
to recollect the sample and send it in the proper container.
ᮃ NOTE: Establish a policy for the proper collection and transport of
clinical specimens not collected on swabs. Educate the physicians that
needles must be removed from the syringe and the syringe cap secured
prior to transport to avoid leakage.
d. Syringes that have been capped with a Luer-Lok (with needle removed)
prior to transport may be accepted for culture provided the specimen has
not clotted inside the syringe and there is no leakage during transport
which could result in contamination of the culture. The laboratory may
reject specimens that have clotted in a capped syringe because they cannot
be processed for culture without inadvertently contaminating the speci-
men.
D. Specimen transport
1. Submit to laboratory as soon as possible and, if from a normally sterile site,
alert laboratory that specimen has been submitted.
2. Do not refrigerate.
3. Label specimens with patient demographics and date, time, and site of col-
lection: e.g., left knee joint fluid.
4. Record the patient diagnosis for improved processing of specimen.
3.5.3 Aerobic Bacteriology
II. SPECIMEN COLLECTION,
TRANSPORT, AND HANDLING
(continued)](https://image.slidesharecdn.com/microbiologyhandbook-150627125246-lva1-app6892/85/Microbiology-handbook-184-320.jpg)
![Body Fluid Cultures (Excluding Blood, CSF, and Urine) 3.5.4
III. MATERIALS A. Media
1. BAP
2. CHOC
3. MAC
4. Nonselective anaerobic medium,
e.g., CDC anaerobic sheep blood
agar. See section 4 for media and
methods.
5. Special selective media for recov-
ery of fastidious or unusual organ-
isms (e.g., charcoal-yeast extract
agar for Legionella). Refer to the
table of contents for procedures for
specific microorganisms.
6. Add media selective for gram-neg-
ative or gram-positive organisms
(see Table 3.3.1–1) based on Gram-
stained smear of the specimen,
which shows multiple morpholo-
gies of microorganisms.
7. Broth known to support the growth
of both fastidious aerobic organ-
isms and anaerobes, to detect small
numbers of organisms (6, 14, 15,
17, 19). Common broth culture me-
dia are as follows.
a. Blood culture bottles (added
supplements have not been
shown to be important [5, 10])
b. Anaerobic BHI or TSB with
0.1% agar with or without yeast
extract
c. Fastidious anaerobe broth or fas-
tidious broth (Quelab Laborato-
ries, Inc., Montreal, Quebec,
Canada; Remel, Inc., Lenexa,
KS) (19)
d. Brucella broth
e. THIO is least desirable as a
broth to grow low numbers of
aerobic organisms and yeasts. It
is excellent for anaerobic organ-
isms (17, 19).
8. See procedure 3.17 for biochemical
test reagents and procedure 3.3.1
for medium descriptions.
B. Gram stain reagents
C. Other supplies
1. Cytocentrifuge and holders
2. Cleaned glass slides
3. Sterile Pasteur pipettes
4. CO2-generating system and 35ЊC
incubator
E. Rejection criteria
1. If only blood culture bottles are received, a Gram stain cannot be performed.
2. Collect prior to antimicrobial therapy for greatest diagnostic sensitivity.
3. Do not submit specimens from drains after they have been infused with
antimicrobial agents.
4. Call physician when fluid specimens are received on a swab.
ᮃ NOTE: Swabs afford the least desirable sample for culture of body fluids
and should be discouraged as devices for transport, since the quantity of
sample may not be sufficient to ensure recovery of a small number of or-
ganisms.
5. Contact physician if specimen is insufficient for the number of tests re-
quested.
ᮃ NOTE: Routine bacterial culture is sufficient for culture for Candida spe-
cies, if blood culture bottles are used or specimen is centrifuged. Fungal
cultures of joint and abdominal specimens are occasionally indicated (es-
pecially for Blastomyces dermatitidis and Histoplasma capsulatum) but
should be discouraged routinely. AFB cultures should not be routine but
should be limited to those with a clinical indication.
6. Invasively collected specimens in leaky containers must be processed, but
alert the physician of the possibility of contamination.
II. SPECIMEN COLLECTION,
TRANSPORT, AND HANDLING
(continued)](https://image.slidesharecdn.com/microbiologyhandbook-150627125246-lva1-app6892/85/Microbiology-handbook-185-320.jpg)









![Catheter Tip Cultures 3.6.5
VII. INTERPRETATION A. Antimicrobial susceptibility testing should be performed on isolates both from
blood and from the catheter tip and other segments submitted to the laboratory
for culture. Different bacterial morphotypes isolated from the blood and the
catheter may only be recognized by variations in their antibiogram profiles. If
a central catheter cannot be immediately removed for clinical reasons (e.g., risk
of bleeding), then antimicrobial therapy is directed against the antimicrobial
susceptibility profile of the blood isolate. In cases where the antimicrobial pro-
files of the blood and catheter isolate(s) are different, then antimicrobial therapy
is directed against the most resistant morphotype isolated from either site.
B. The presence of Ͼ15 CFU suggests the catheter as a potential source of bac-
teremia, which occurs with about 10% of colonized catheters.
3. Report minimal identification of pure cultures of skin microbiota, e.g., staph-
ylococci or gram-positive rods.
C. If organisms are too numerous to count, report as “Ͼ100 CFU.”
D. Report preliminary negative cultures as “No growth at x days,” where “x” is the
number of days of incubation. Report final negative cultures as, e.g., “No growth
at 4 days.”
E. If gram-negative rods or S. aureus is isolated and no blood culture was sub-
mitted, add the following note to the report: “Submit blood cultures to diagnose
catheter-related sepsis.”
P O S T A N A L Y T I C A L C O N S I D E R A T I O N S
VI. REPORTING RESULTS A. For any morphotype with a count of Ͼ15 CFU
1. Enter the number of CFU isolated for each organism; i.e., 18 CFU followed
by the organism name, at least to the genus level.
ᮃ NOTE: Organisms are not enumerated in catheter tip cultures as few,
moderate, and numerous.
2. For gram-positive rods, report as “Coryneform rods; not otherwise specified”
if reactions are appropriate per Table 3.3.2–5.
3. If different morphologies of coagulase-negative staphylococci are present,
report “[number] CFU of coagulase-negative staphylococci (mixed mor-
phologies).”
B. If any morphotype has Ͻ15 CFU
1. Report significant pathogens by name.
2. Group together mixed skin microbiota organisms (i.e., coagulase-negative
Staphylococcus, diphtheroids, non-Candida albicans yeasts, Acinetobacter,
or viridans group streptococci) as, e.g., “25 CFU of mixed skin microbiota.”
VIII. LIMITATIONS A. Semiquantitative catheter tip cultures are estimated to have a sensitivity of 85%
in diagnosis of catheter-related bacteremia, but the specificity to diagnose cath-
eter-related sepsis is low (14). Blood cultures collected from peripheral sites are
helpful in confirmation of the diagnosis of catheter-related sepsis (1, 5, 7).
B. Infections of the catheter hub lumen may be missed by culture of only the tip.
C. Efforts to diagnose catheter-related sepsis using unpaired quantitative blood
cultures drawn from the catheter are less sensitive than tip cultures (14).
D. Catheter cultures can be helpful in determination of the cause of fever.
E. Some authors have shown that quantitative catheter tip cultures have a greater
sensitivity and specificity than the semiquantitative method of Maki et al. (7) in
the diagnosis of catheter-related sepsis; however, these methods are more labor-
intensive (2, 6, 10, 12–14). See Appendix 3.6–1 for method.](https://image.slidesharecdn.com/microbiologyhandbook-150627125246-lva1-app6892/85/Microbiology-handbook-195-320.jpg)
















![3.8.1.5 Aerobic Bacteriology
III. MATERIALS A. Media for routine stool culture (see
Table 3.8.1–1 for descriptions and ab-
breviations)
1. BAP
2. MAC
3. Choose one or more (to increase
yield) of the following to select for
Salmonella and Shigella.
a. HEK
b. XLD
c. CHROMagar Salmonella
d. SS (do not use as only selective
medium)
4. Enrichment broth (choose one)
a. Selenite-F (generally for Sal-
monella enrichment)
b. GN broth (for both Salmonella
and Shigella enrichment, but re-
quires subculture at 6 to 8 h)
ᮃ NOTE: The use of enrichment
broths for detecting small numbers
of Salmonella or Shigella spp. can
be justified for culturing stools of
workers in sensitive occupations,
such as day care workers and food
service employees. Laboratories
that have historical data showing
very poor recovery of additional
pathogens not seen on initial plates
can make a case for abandoning
routine use of enrichment broths.
Generally enrichment broth in-
creases the yield of Salmonella and
Shigella by 10%.
5. If selected other pathogens are re-
quested or indicated, choose addi-
tional selective media from Table
3.8.1–2 to enhance recovery of
these stool pathogens. Also use
these media based on prevalence of
disease and public health require-
ments in specific geographic areas
(e.g., use bismuth sulfite agar for
cluster epidemics of Salmonella).
B. Biochemical tests
1. For screening and detection of Sal-
monella, Shigella, and Yersinia
a. Spot indole reagent (procedure
3.17.23)
b. Oxidase reagent (procedure
3.17.39)
ᮃ NOTE: False-negative re-
sults are common if indole or
oxidase test is done from selec-
tive medium. Test only from
BAP.
c. Urea agar slants or disks (pro-
cedure 3.17.48)
d. Kligler’s iron agar (KIA) or tri-
ple sugar iron agar (TSI) slants
(procedures 3.17.22 and
3.17.25)
e. Andrade’s glucose with a Dur-
ham tube for gas production (op-
tional) (procedure 3.17.9)
ᮃ NOTE: This medium allows
easy reading of gas production
and can be used for motility and
Voges-Proskauer (VP) reaction.
f. Pyrrolidonyl-b-naphthylamide
(PYR) (procedure 3.17.41)
g. Semisolid motility medium
(procedure 3.17.31)
h. Kit identification system (API
20E, IDS panel, Vitek GNI Plus
card [bioMe´rieux, Inc.];
MicroScan gram-negative iden-
tification panels [Dade Behring
MicroScan Microbiology Sys-
tems]; BD CRYSTAL [BD Di-
agnostic Systems]; etc.)
i. Acetate for problematic Shi-
gella identifications (procedure
3.17.2)
j. Antisera for grouping (see Ap-
pendix 3.8.1–1)
(1) Salmonella polyvalent and
Vi (optional, A, B, C1, C2,
and D)
(2) Shigella groups A, B, C,
and D or
(3) Salmonella and Shigella
colored latex agglutination
reagents (Wellcolex; Remel
Inc., Lenexa, KS)
2. For Vibrio and Aeromonas
a. O/129 disks–150 lg (procedure
3.17.36)
b. Mueller-Hinton agar (MH) with
and without 4% salt
c. Esculin slants or broth (optional
for identification of Aeromonas
to species level) (procedure
3.17.5)
d. O1 antiserum and toxigenicity
kit (optional)
ᮃ NOTE: Vibrio toxin testing is
performed by latex test, DNA
probe, EIA, or tissue culture. One
source is Unipath Co., Oxoid, Og-
denburg, NY (V. cholerae toxige-
nicity kit, VET-RPLA).
3. For E. coli O157
a. 4-Methylumbelliferyl-b-D-glu-
curonide test (MUG) (procedure
3.17.34)](https://image.slidesharecdn.com/microbiologyhandbook-150627125246-lva1-app6892/85/Microbiology-handbook-212-320.jpg)








![Fecal Culture for Aerobic Pathogens of Gastroenteritis 3.8.1.14
(1) Only serovar Typhi will type in both group D and in Vi antisera, is
ornithine decarboxylase negative, and produces no gas and little H2S
from carbohydrates in KIA or TSI.
ᮃ NOTE: Serovar Paratyphi C will also agglutinate in Vi antiserum.
(2) Serovar Paratyphi A will type in group A antiserum and is citrate and
lysine decarboxylase negative.
(3) Serovar Choleraesuis will type in group C antiserum and is arabinose
and trehalose negative.
n. Submit all Salmonella (and Shigella, if typing is not available or if sub-
mission is required by local policy) isolates to the health department for
confirmatory identification and for typing.
o. Perform AST on all enteric pathogens except E. coli O157, because treat-
ment has been shown to predispose children to HUS (24, 25). Since
enteric bacterial gastroenteritis is a self-limited illness in otherwise
healthy children and adults, AST results should not be routinely reported
except for in the following clinical situations:
(1) At the request of the physician
(2) Patient has disseminated infection with positive urine, blood, or other
sterile fluid cultures.
(3) Salmonella serovar Typhi infection regardless of patient’s age
(4) Shigella infection
(5) Salmonella infection in a child Ͻ1 year of age
(6) Salmonella infection in an adult Ͼ65 years of age
(7) Immunocompromised patients, including human immunodeficiency
virus/AIDS
3. Screen CIN at 24 and 48 h.
a. Look for any colonies with a deep red center with a sharp border sur-
rounded by a translucent zone.
b. Inoculate BAP and identification kit.
c. Check oxidase reaction. If positive, follow Fig. 3.8.1–1 to identify Aero-
monas.
d. If oxidase negative, inoculate Andrade’s glucose (or methyl red-VP [MR-
VP] broth) and motility semisolid medium at both 25 and 35ЊC.
e. Read VP and motility at 24 h to confirm kit identification.
(1) Y. enterocolitica and Yersinia pseudotuberculosis are nonmotile and
VP negative at 35ЊC and motile at 25ЊC (10).
(2) Y. enterocolitica is VP positive at 25ЊC, but Y. pseudotuberculosis is
VP negative.
(3) Both are usually urease positive.
V. PROCEDURE (continued)
Table 3.8.1–5 Biochemical differentiation of selected members of the Salmonella groupa
Test
Serogroup
Choleraesuis
Serogroup
Paratyphi A
Serogroup
Typhi
Other
Salmonella group C A D A–E
Arabinose fermentation מ ם מ ם
Citrate utilization V מ מ ם
Glucose gas production ם ם מ ם
Lysine decarboxylase ם מ ם ם
Ornithine decarboxylase ם ם מ ם
Rhamnose fermentation ם ם מ ם
Trehalose fermentation מ ם ם ם
a
Symbols: ,מ Յ9% of strains positive; V, 10 to 89% of strains positive; ,ם Ն90% of strains positive.](https://image.slidesharecdn.com/microbiologyhandbook-150627125246-lva1-app6892/85/Microbiology-handbook-221-320.jpg)

![Fecal Culture for Aerobic Pathogens of Gastroenteritis 3.8.1.16
P O S T A N A L Y T I C A L C O N S I D E R A T I O N S
VI. REPORTING RESULTS A. Record biochemical results on colonies being screened on appropriate work-
sheets, noting media sampled and enumeration.
B. Negative cultures
1. For all stool cultures, report a pathogen-negative comment that specifies all
of the enteric bacterial pathogens the laboratory has tested for. For example,
report “No Salmonella, Shigella, or Campylobacter sp. isolate” if these are
the only pathogens routinely tested.
2. If additional pathogens have been ruled out, the comment should be ex-
panded to also list other culture-negative results. Include a comment such as
“No E. coli O157, Yersinia, Aeromonas, or Vibrio detected.”
3. Add “to date” for preliminary reports and delete for final reports.
C. Additional comments
1. If gram-negative enteric microbiota are not present in the culture, add a
comment: “No normal enteric gram-negative rods isolated.”
2. Report overgrowth of predominant S. aureus and P. aeruginosa as “Predom-
inating or pure culture of [organism name].”
ᮃ NOTE: The presence of S. aureus may or may not indicate gastrointes-
tinal disease or food poisoning. Toxin must be detected in stool or food for
disease, which is rarely done.
3. Report yeast, if found in pure or predominating culture, without genus or
species identification.
4. In the setting of diarrhea and no other likely cause, report a pure culture of
unusual microbiota, such as DF-3 or Klebsiella spp.
D. Positive cultures
1. Report presumptive presence of any enteric pathogens listed in Table 3.8.1–
6 with or without quantitation, depending on laboratory’s policy to track
positive cultures from enrichment broth only.
2. Report the pathogen with the preliminary designation as “probable” until the
identification is confirmed by both biochemical testing and serology.
3. Enter preliminary note indicating that “Isolate has been sent for confirmatory
identification to [name and location]” when isolate has been sent for sero-
logic testing.
4. Salmonella reporting
ᮃ NOTE: Salmonella nomenclature is a topic of worldwide debate at the
present time (4). There is only one species of Salmonella that infects humans;
some call this species Salmonella enterica and others refer to it as Salmonella
choleraesuis. In addition, the species is divided into six subspecies and over
2,000 serotypes. Serotypes are grouped into several serogroups noted alpha-
betically as A, B, C1, C2, etc. Serotype names are called either serovars or
serotypes and are not in italics. Some texts capitalize the serotype name and
others do not. Because the long names are cumbersome and laboratory com-
puter systems do not italicize, Salmonella enterica subsp. enterica serotype
Typhimurium is usually called Salmonella typhimurium or Salmonella ser-
ovar Typhimurium on laboratory reports.
a. Report the following to the serotype level: Salmonella serovar Paratyphi
A, Salmonella serovar Choleraesuis, or Salmonella serovar Typhi, using
Table 3.8.1–5.
b. Report isolates that are serologically A, C, or D, but are not biochemically
serovar Paratyphi A, serovar Choleraesuis, or serovar Typhi, as follows.
(1) Salmonella serogroup A—not Paratyphi A
(2) Salmonella serogroup C—not Choleraesuis
(3) Salmonella serogroup D—not Typhi](https://image.slidesharecdn.com/microbiologyhandbook-150627125246-lva1-app6892/85/Microbiology-handbook-223-320.jpg)




![3.8.1.21 Aerobic Bacteriology
APPENDIX 3.8.1–1 Detection of Somatic O Antigen Serogroups of Bacteria
I. PRINCIPLE
Gram-negative rods possess somatic antigens in their cell walls, called O antigens, that
are useful in the identification of specific serovars or serotypes. These antigens are
polysaccharide side chains of endotoxin in the outer membrane of the cell wall. Anti-
body to these antigens will agglutinate a suspension of the organism.
II. SPECIMEN
Prepare milky suspension of pure culture from fresh plate in normal sterile saline. If
culture is not pure, erroneous results can occur.
III. MATERIALS
A. Antisera
1. Salmonella polyvalent, A, B, C1, C2, D, E, etc., and Vi; Shigella groups A, B,
C, and D; E. coli O157; V. cholerae O1, or any other serotype
2. Store antisera at 4ЊC.
B. Petri dishes and either glass slides or disposable cards with black background (pre-
ferred)
IV. QUALITY CONTROL
Test each lot of reagent with a known positively and negatively reacting organism prior
to putting into use it and every 6 months thereafter. Organisms can be stored in formalin
at 4ЊC for QC use.
V. PROCEDURE
Mix drop of antiserum with drop of suspension of organism. Rotate slide for 1 min and
observe for agglutination.
VI. INTERPRETATION
Positive agglutination is an indication that the strain contains O antigen.
VII. REPORTING RESULTS
Report presumptive identification as “[organism name]” followed by serotype alpha and
numeric designation.
VIII. LIMITATIONS
A. Some organisms with either capsules or flagella can give a false-negative result.
Boil the suspension for 5 min or test Salmonella using Vi antigen for the capsule
of this genus.
B. Serological identification should be confirmed with biochemical testing, since se-
rotypes can be shared or cross-react with other species.
Supplemental Reading
Ewing, W. H. 1986. Edwards and Ewing’s Iden-
tification of Enterobacteriaceae, 4th ed. Elsevier
Science Publishing Co., New York, NY.
Observe standard precautions.
SUPPLEMENTAL READING Ewing, W. H. (ed.). 1986. Edwards and Ewing’s
Identification of Enterobacteriaceae, 4th ed. El-
sevier Science Publishing Co., New York, NY.
Gilligan, P. H., J. M. Janda, M. A. Karmali,
and J. M. Miller. 1992. Cumitech 12A, Labora-
tory Diagnosis of Bacterial Diarrhea. Coordinat-
ing ed., F. S. Nolte. American Society for Micro-
biology, Washington, DC.
Jeppesen, C. 1995. Media for Aeromonas spp.,
Plesiomonas shigelloides and Pseudomonas spp.
from food and environment. Int. J. Food Micro-
biol. 26:25–41.
Karch, H., and M. Bielaszewska. 2001. Sorbitol-
fermenting Shiga toxin-producing Escherichia
coli O157:H()מ strains: epidemiology, pheno-
typic and molecular characteristics, and microbi-
ological diagnosis. J. Clin. Microbiol. 39:2043–
2049.
McFaddin, J. F. 1985. Media for Isolation, Cul-
tivation, Identification, and Maintenance of Bac-
teria, vol. I. Williams & Wilkins, Baltimore, MD.
Mead, P. S., L. Slutsker, V. Dietz, L. F. McCaig,
J. S. Bresee, C. Shapiro, P. M. Griffin, and R.
V. Tauxe. 1999. Food-related illness and death in
the United States. Emerg. Infect. Dis. 5:607–625.](https://image.slidesharecdn.com/microbiologyhandbook-150627125246-lva1-app6892/85/Microbiology-handbook-228-320.jpg)


![3.8.2.1
3.8.2 Fecal Culture for Campylobacter and
Related Organisms
P R E A N A L Y T I C A L C O N S I D E R A T I O N S
I. PRINCIPLE
Using recently developed genetic tech-
niques, the genus Campylobacter was di-
vided into three genera based on 16S
rRNA homology tests (22). The groups
Campylobacter, Helicobacter, and Arco-
bacter are microaerobic to anaerobic or-
ganisms. These curved, helical, gram-neg-
ative rods are among the most challenging
bacteria for the clinical microbiologist to
cultivate and identify. In addition, the dis-
ease spectrum with these genera ranges
from “well established” (as in the associ-
ation of Campylobacter jejuni and diar-
rhea) to “speculative” (associated with
clinical strains such as Arcobacter species
that have unproven etiology) to “emerg-
ing” (such as C. upsaliensis and Helico-
bacter rappini [“Flexispira rappini”]).
Table 3.8.2–1 lists the taxonomic po-
sitions, known sources, and common dis-
ease associations for campylobacters, hel-
icobacters, arcobacters, and other,
unrelated genera that are sometimes con-
fused with campylobacters (16). In Table
3.8.2–2, clinical diseases and their possi-
ble causative agents are listed. Because of
diverse growth requirements, such as tem-
perature, atmosphere of incubation, etc.,
most clinical laboratory methods are de-
signed to recover only the most common
pathogenic strains of these genera. While
this procedure focuses on fecal cultures,
these basic methods can be used to iden-
tify campylobacters from most cultures.
For Helicobacter pylori, refer to procedure
3.8.4.
It is estimated that Campylobacter
causes approximately 2.4 million cases of
disease each year in the United States. C.
jejuni is the most commonly identified
bacterial pathogen isolated from fecal cul-
tures, with greater than 90% of campylo-
bacter infections caused by C. jejuni (7).
C. jejuni gastroenteritis is a self-limiting
disease, but severe infections occur in the
young and immunocompromised. The
procedure that follows is designed to de-
tect and identify C. jejuni. Although other
species have been associated with gastro-
enteritis, they are more difficult to isolate
and identify to the species level. Conse-
quently, culture of these other species can-
not be justified in most clinical laborato-
ries.
Because Campylobacter spp. and
Escherichia coli O157:H7 are the major
contributors to blood in the stool, it is
important to detect the presence of the in-
fecting organism, since the use of antimi-
crobial treatment for E. coli O157 infec-
tion is thought to increase the risk of
hemolytic-uremic syndrome. The drug of
choice for treatment of campylobacters
was ciprofloxacin, because it is effective
for both Campylobacter and other enteric
pathogens. The use of quinolones in the
poultry industry has increased resistance
of campylobacters to quinolones, with
rates of 10% (1) to as high as 40% (15).
Erythromycin is returning as the drug of
choice for treatment, although occasional
resistance is also seen with this agent.
Newer macrolides are also effective but
are more expensive.
II. SPECIMEN COLLECTION,
TRANSPORT, AND HANDLING
A. Specimen collection
1. See procedure 3.8.1 for fecal and rectal swab collection.
2. Campylobacter can be isolated from routine anaerobic cultures of blood or
wound specimens. If isolate does not grow on subculture, incubate in a mi-
croaerobic atmosphere at 35ЊC for possible campylobacter or helicobacter
isolation.
Observe standard precautions.](https://image.slidesharecdn.com/microbiologyhandbook-150627125246-lva1-app6892/85/Microbiology-handbook-231-320.jpg)
![3.8.2.2 Aerobic Bacteriology
Table 3.8.2–1 Taxonomic position, known sources, and common disease associations of Campylobacter, Arcobacter, Helicobacter, and
related speciesa
Disease association(s)
Taxonb
Known source(s)
Human Veterinary
rRNA homology group I
Campylobacter fetus subsp. fetus
(‘Campylobacter fetus subsp. in-
testinalis’)
Cattle, sheep Septicemia, gastroenteritis,
abortion, meningitis
Bovine and ovine spontane-
ous abortion
Campylobacter fetus subsp. vener-
ealis (‘Campylobacter fetus
subsp. fetus’)
Cattle Septicemia Bovine infectious infertility
Campylobacter hyointestinalis
subsp. hyointestinalisc
Pigs, cattle, hamsters, deer Gastroenteritis Porcine and bovine enteritis
Campylobacter hyointestinalis
subsp. lawsoniib
Pigs None at present Unknown
Campylobacter concisus Humans Periodontal disease, gastro-
enteritis
None at present
Campylobacter mucosalis (“Campy-
lobacter sputorum subsp. mucos-
alis”)
Pigs None at present Porcine necrotic enteritis and
ileitis
Campylobacter sputorum bv. Spu-
torum (incorporating bv. Bubu-
lusd
)
Humans, cattle, pigs Abscesses, gastroenteritis None at present
Campylobacter sputorum bv. Faeca-
lis (‘Campylobacter fecalis’)
Sheep, bulls None at present None at present
Campylobacter curvus (“Wolinella
curva”)
Humans Periodontal disease, gastro-
enteritis
None at present
Campylobacter rectus (“Wolinella
recta”)
Humans Periodontal disease None at present
Campylobacter showaeb
(‘Wolinella
curva subsp. intermedius’)
Humans Periodontal disease None at present
Campylobacter gracilisd
(“Bacter-
oides gracilis”)
Humans Periodontal disease, empy-
ema, abscesses
None at present
Campylobacter upsaliensis (‘CNW
Campylobacter’)
Dogs, cats Gastroenteritis, septicemia,
abscesses
Canine and feline gastroen-
teritis
Campylobacter helveticusc
Cats, dogs None at present Feline and canine gastroen-
teritis
Campylobacter hyoileic,h
Pigs None at present Porcine proliferative enteritis
Campylobacter coli Pigs, poultry, bulls, sheep,
birds
Gastroenteritis, septicemia Gastroenteritis
Campylobacter jejuni subsp. jejuni Poultry, pigs, bulls, dogs,
cats, water, birds, mink,
rabbits, insects
Gastroenteritis, septicemia,
meningitis, abortion, proc-
titis, Guillain-Barre´ syn-
drome
Gastroenteritis, avian hepati-
tis
Campylobacter jejuni subsp. doylei
(‘NNC group’)
Humans Gastroenteritis, gastritis, sep-
ticemia
None at present
Campylobacter lari (“Campylobac-
ter laridis.” ‘NARTC’)
Birds (including poultry),
river water and seawater,
dogs, cats, monkeys,
horses, fur seals
Gastroenteritis, septicemia Avian gastroenteritis
Bacteroides [Campylobacter] ureo-
lyticuse
Humans Nongonococcal urethritis, ne-
crotic tissue lesions, in-
fected amniotic fluid,
wound infections
None at present
“rRNA homology group Ia”
Campylobacter-like, unnamed free-
living speciese
Anaerobic sludge None at present None at present](https://image.slidesharecdn.com/microbiologyhandbook-150627125246-lva1-app6892/85/Microbiology-handbook-232-320.jpg)



![3.8.2.6 Aerobic Bacteriology
Table 3.8.2–3 Commercial systems for generating microaerobic environments and the
approximate atmospheric content
System Final atmosphere
BBL Campy Pak 6.9% O2, 5.5–7.0% CO2, 0.2% H2
BBL Campy Pouch 7.5–9.0% O2, 11.5–14% CO2, 0.5–1.5% H2
BBL Bio Bag Cfj 10.5–15% O2, 7–15% CO2, 6.5–12.5% H2
Oxoid CampyGena
6% O2, 15% CO2
Mitsubishi Pack-Campyloa
6% O2, 14% CO2
a
This system produces negligible H2 and may not grow H2-requiring species.
2. Blood-free charcoal-cefoperazone-
desoxycholate agar (CCDA) con-
tains desoxycholate, charcoal base
(CM 739; Oxoid), and cefopera-
zone (9).
3. Campy-CVA contains brucella
agar with 5% sheep blood, cefo-
perazone, vancomycin, and ampho-
tericin B.
B. Stain reagents
1. Gram stain (procedure 3.2.1) with
carbol fuchsin or 0.1% basic fuch-
sin for colony smears
2. Acridine orange (procedure 3.2.2)
for problem cultures
3. Wet mount (procedure 3.2.3) for di-
rect specimen
C. Other supplies
1. A microaerobic environment
ᮃ NOTE: Most campylobacters
require a microaerobic environ-
ment of approximately 5% O2 and
85% N2 for optimal growth. In-
creased H2 appears to be a growth
requirement for the more fastidious
campylobacters (C. sputorum, C.
concisus, C. curvus, C. mucosalis,
and some strains of C. hyointestin-
alis). These strains are not of sig-
nificance in fecal cultures, but they
may be isolated from blood and
may require anaerobic incubation
for growth.
a. Use an anaerobic jar, without a
catalyst, and a gas mixture con-
taining 10% CO2–5% H2–bal-
ance N2. Evacuate and fill jar
two times to achieve a final at-
mosphere of 5% O2, 7% CO2,
and 4% H2.
b. Alternatively, use a leakproof
Saranex zipper bag (Associated
Bag Company, [800] 926-6100)
and fill once with 5% O2, 10%
CO2, balance N2 (Campy Gas
Cylinder, catalog no. S0730;
PML Microbiologicals, Inc.,
Wilsonville, OR, [800] 547-
0659, http://www.pmlmicro.
com)
c. See Table 3.8.2–3 for commer-
cial gas systems.
2. Incubator at 42 and 35ЊC
3. Identification—media and bio-
chemical tests
a. Heart infusion agar with 5%
rabbit blood (BBL catalog no.
297472; BD Diagnostic Sys-
tems), BAP, or brucella agar
with 5% sheep blood for disk
tests and temperature growth
tests
b. Heart infusion broth (HIB) or
BHI for inoculum preparation
(BD Diagnostic Systems)
c. Oxidase (procedure 3.17.39)
d. Catalase (3% H2O2) (procedure
3.17.10)
e. Hippurate (procedure 3.17.21
and reference 13)
f. Indoxyl acetate disks (procedure
3.17.24 and reference 19)
g. Rapid urea hydrolysis (proce-
dure 3.17.48 and references 12
and 17)
h. Disks—store at 02מЊC (BD Di-
agnostic Systems; Remel, Inc.).
(1) Nalidixic acid (NA) disks,
30 lg
(2) Cephalothin or cefazolin
(CF [abbreviation stands for
either drug]) disks, 30 lg
(3) Ciprofloxacin, 5 lg, and
erythromycin, 15 lg, disks
(optional)
i. Nitrate test (procedure 3.17.35)
j. Triple sugar iron (TSI) (proce-
dure 3.17.22)
ᮃ NOTE: For use in the iden-
tification of campylobacters,
TSI must be freshly prepared
and used within 1 week (CDC
Campylobacter Reference Lab
Procedure Manual). Incubate
test at 35ЊC for 72 h before call-
ing result negative.
III. MATERIALS (continued)](https://image.slidesharecdn.com/microbiologyhandbook-150627125246-lva1-app6892/85/Microbiology-handbook-236-320.jpg)

![CVA. Alternatively inoculate plates using a swab dipped into the transport
vial, and completely roll the swab on the medium plate in an area the size
of a nickel.
b. Streak in four quadrants.
c. Place the plate immediately in a microaerobic environment.
d. Incubate at 42ЊC for 72 h to screen for thermotolerant Campylobacter
and Helicobacter species.
ᮃ NOTE: If detection of species other than C. jejuni and C. coli is desired,
incubate a second plate at 35 to 37ЊC. Since most species that do not grow
at 42ЊC will grow at 40ЊC, use of a 40ЊC incubator will allow one temperature
to be used for all species.
2. Feces—filtration technique
ᮃ NOTE: This technique has been successful for isolation of campylobac-
ters that are susceptible to antimicrobial agents in media. Passage of motile
campylobacters through the pores of the filter allows for selective separation
of campylobacters from the nonmotile stool constituents. This method will
yield a large variety of Campylobacter species, not all of which have been
clearly linked with disease.
a. Place a sterile cellulose acetate membrane filter, with a 47-mm diameter
and a 0.65-lm pore size (Sartorius Corp., Edgewood, NY, [800] 635-
2906, http://www.sartorius.com), directly on the surface of a BAP.
b. Add 6 to 8 drops of the stool directly on the filter.
c. Incubate for 45 min to 1 h in ambient air at 35 to 37ЊC.
d. Remove filter with sterile forceps, taking care not to allow any residual
stool on the filter to drip on the plate. Do not streak for isolation.
e. Immediately place the plate in a microaerobic environment at 35 to 37ЊC
for a minimum of 72 h or up to 6 days for recovery of fastidious and slow-
growing organisms (5).
D. Identification methods
1. Examine direct plates for growth of campylobacters.
a. On freshly prepared media, colonies are gray, flat, irregular, and spread-
ing; sometimes they may appear mucoid.
b. Some strains will appear as a thin film on the medium and require careful
observation to detect growth (best done by scraping a loop over the sur-
face of the medium). They can also appear as colonies that tail along the
line of streaking.
c. On less fresh medium, colonies, 1 to 2 mm in diameter, appear as gray,
round, convex, and glistening, with little or no spreading.
d. Colonies can be yellowish to gray or pinkish and are nonhemolytic.
e. Helicobacter cinaedi and Helicobacter fennelliae growth on fresh media
in a moist environment may spread as a uniform film over the entire
surface of the plate. H. fennelliae has the distinct odor of hypochlorite.
They require 5 to 10% hydrogen for growth and generally do not grow
at 42ЊC.
f. Check aerobic BAP (procedure 3.8.1) for oxidase-positive colonies at 24
h, which are likely Pseudomonas or Aeromonas. Then reincubate if neg-
ative and recheck at 96 h. If positive at 4 to 5 days and not at 48 h,
Arcobacter could be present.
2. Perform Gram stain on suspicious colonies using basic fuchsin or carbol
fuchsin counterstain promptly after removal from the microaerobic environ-
ment.
a. Look for small gram-negative rods shaped like spirals, gull wings, archery
bows, or commas, consistent with Campylobacter species. Coccoidal
forms may be seen in the Gram stain, especially in older cultures or
cultures exposed to ambient air for prolonged periods.
3.8.2.8 Aerobic Bacteriology
V. PROCEDURE (continued)](https://image.slidesharecdn.com/microbiologyhandbook-150627125246-lva1-app6892/85/Microbiology-handbook-238-320.jpg)



![(6) Interpretation: record the amount of 72-h growth as follows.
(a) No growth
(b) Trace
(c) 1ם (light)
(d) 2ם (moderate)
(e) 3ם (heavy)
9. Other tests
a. Cellular fatty acid analysis (MIDI Laboratories, Newark, DE, [302] 737-
4297, http://www.midi-inc.com/) (10)
ᮃ NOTE: This method cannot differentiate C. jejuni and C. coli, the two
most common species.
b. Species-specific PCR or 16S rDNA sequencing (CDC Campylobacter
Laboratory, Atlanta, GA; MIDI Laboratories)
c. C. jejuni-specific DNA probe (16) (BioProbe; Enzo Diagnostics, Far-
mingdale, NY, [631] 694-7070, http://www.enzobio.com).
d. AccuProbe Campylobacter culture identification test (Gen-Probe, Inc.,
http://www.gen-probe.com/) for DNA identification of C. jejuni/coli/lari
colonies does not differentiate among these three species.
ᮃ NOTE: The AccuProbe system uses a single-stranded DNA probe
with a chemiluminescent label that recognizes RNA sequences that are
unique to C. jejuni, C. coli, and C. lari. Following the release of the target
RNA, the DNA probe forms a stable DNA:RNA hybrid. A selection
reagent inactivates unhybridized probe and the labeled DNA:RNA hy-
brids are detected in a luminometer.
(1) Label a sufficient number of probe reagent tubes to test the number
of culture isolates and a positive (C. jejuni ATCC 33560) and neg-
ative (C. fetus ATCC 27374) control.
(2) Pipette 50 ll of lysis reagent into all tubes.
(3) Transfer a 1-ll loopful of cells or several small colonies (Ͻ48 h old)
to the tubes and twirl the loop to remove the cells. Test a positively
and negatively reacting organism with each run.
(4) Pipette 50 ll of hybridization buffer into all tubes and mix by vor-
texing.
(5) Incubate tubes for 15 min at 60ЊC in a water bath or dry-heat block.
(6) Remove and cool the tubes. Pipette 300 ll of selection reagent to
each tube and mix by vortexing.
(7) Incubate tubes for 5 min at 60ЊC in a water bath or dry-heat block.
(8) Cool the tubes to room temperature and read results in the lumino-
meter within 30 min. Cutoff values for positive and negative signals
are established by the manufacturer for the type of luminometer used.
ᮃ NOTE: The AccuProbe assay was compared to standard culture and
biochemical identification using 301 isolates of thermophilic Campylo-
bacter species (C. jejuni, C. coli, and C. lari), 41 isolates of other Cam-
pylobacter spp., and 300 other bacterial cultures from 53 genera at three
clinical sites. The sensitivities and specificities were 100 and 99.1%, 100
and 100%, and 100 and 100%, respectively. One false positive was de-
tected with C. hyointestinalis (product insert).
e. Oxoid Dryspot Campylobacter test (latex agglutination), product code
DR0150
ᮃ NOTE: The Oxoid Dryspot Campylobacter test is a latex agglutination
test for the identification of enteropathogenic campylobacters from solid
culture media. C. jejuni, C. lari, C. coli, C. fetus, and C. upsaliensis will
give positive results. Isolates of other Campylobacter spp. such as C. fetus
subsp. fetus will give variable results.
3.8.2.12 Aerobic Bacteriology
V. PROCEDURE (continued)](https://image.slidesharecdn.com/microbiologyhandbook-150627125246-lva1-app6892/85/Microbiology-handbook-242-320.jpg)

![3.8.2.14 Aerobic Bacteriology
P O S T A N A L Y T I C A L C O N S I D E R A T I O N S
VI. REPORTING RESULTS A. Direct smears
1. If Gram stain of fecal specimens demonstrates the presence of gull wing-
shaped, curved, gram-negative rods, report as “Presumptive Campylobacter
species.”
2. If wet mount of stool demonstrates darting motility, report as “Presumptive
Campylobacter species.”
B. Culture
1. All Campylobacter and Helicobacter strains are oxidase positive, vibrio-like,
or spiral gram-negative rods that have darting motility.
2. Report “Presumptive Campylobacter species” if the following criteria are
met.
a. Growth has typical colonial morphology on selective media in a microae-
robic environment incubated at 42ЊC.
b. Curved, gram-negative rods are demonstrated on Gram stain from colony.
c. Organism exhibits darting motility.
d. Organism is oxidase positive and catalase positive.
3. Use the biochemical tests listed in Table 3.8.2–4 and the flowchart in Fig.
3.8.2–1 to differentiate Campylobacter and Helicobacter species of human
importance. Report C. jejuni, C. jejuni subsp. doylei, C. jejuni/coli, C. lari,
or Helicobacter pullorum based on the flowchart in Fig. 3.8.2–1.
4. If isolate is not identified by Fig. 3.8.2–1, report species as denoted by bio-
chemical characterization in Table 3.8.2–4.
5. If unable to identify isolates using the above schemes or to confirm identi-
fication, submit to a reference laboratory. Report “Campylobacter-like or-
ganism; submitted to reference laboratory for definitive identification.”
ᮃ NOTE: For definitive identification, cellular fatty acid analysis and/or
molecular analysis may be required.
C. Susceptibility testing
1. Standardized antimicrobial susceptibility testing methods for testing the sus-
ceptibility of Campylobacter isolates, with the exception of the agar dilution
method, are not available.
2. However, the lack of a zone around either erythromycin or ciprofloxacin
disks indicates that the isolate is likely resistant to the antimicrobial agent.
ᮃ NOTE: In over 200 disk diffusion tests with erythromycin and ciproflox-
acin, there was consistently a bimodal distribution of results, with most re-
sults either at Ն25 mm or showing no zone (6 mm). More recently, zone
sizes have been found to be smaller, but the bimodal distribution is still valid.
No Campylobacter isolates have been found that are susceptible to NA (large
zone) but resistant to ciprofloxacin (no zone) (R. Nadarajah, personal com-
munication).
3. If there is no zone around the ciprofloxacin or erythromycin disk, enter the
following: “By a nonstandard susceptibility test method, isolate is resistant
to [drug].”
4. Do not report any isolate as susceptible, since there are no standardized
interpretive criteria for Campylobacter.
D. Notification
1. Notify caregiver of positive findings.
2. Report Campylobacter in fecal cultures to the local health department, per
local reportable-disease regulations.](https://image.slidesharecdn.com/microbiologyhandbook-150627125246-lva1-app6892/85/Microbiology-handbook-244-320.jpg)





![3.8.3.1
3.8.3 Clostridium difficile Toxin Detection
P R E A N A L Y T I C A L C O N S I D E R A T I O N S
I. PRINCIPLE
Clostridium difficile is an opportunistic
pathogen present in healthy adults and
children and is responsible for 300,000 to
3,000,000 cases of diarrhea and colitis in
hospitalized patients in the United States
every year (12). When the intestinal mi-
crobiota is altered, toxigenic C. difficile
flourishes and toxin production increases.
C. difficile toxin is responsible for 25% of
antimicrobial agent-associated diarrhea
cases and almost all cases of pseudomem-
branous colitis (11). Patients with the lat-
ter present with pseudomembranous nod-
ules or plaques in the distal and sigmoid
colon and rectum, which lead to colonic
dilation (toxic megacolon) or even perfo-
ration. If unrecognized or untreated, it can
be fatal. The definitive diagnosis of pseu-
domembranous colitis is made by the en-
doscopic detection of pseudomembranes
or microabscesses.
For hospitalized patients, C. difficile-
associated diarrhea (CDAD) correlates
with antimicrobial therapy within the last
30 days and either three unformed stools
over a 24-h period or abdominal pain (6).
Although clindamycin and cephalosporin
usage is highly associated with the dis-
ease, any antimicrobial agent can precipi-
tate toxin production, as can various anti-
cancer chemotherapeutic agents and
diseases, such as AIDS. Generally, the im-
plicated antimicrobial agent is discontin-
ued, and treatment with oral vancomycin
or metronidazole may be needed. The lat-
ter agent is preferred to prevent the emer-
gence of vancomycin-resistant entero-
cocci.
Nosocomial spread of C. difficile can
be a problem, particularly in hospitals with
neutropenic patients or long-term- care pa-
tients. The Society for Healthcare Epide-
miology of America (SHEA) and America
College of Gastroenterology have issued
separate guidelines for prevention and
control of C. difficile disease (3, 4). C. dif-
ficile produces two toxins, enterotoxin
(toxin A) and cytotoxin (toxin B). Toxin
A causes extensive tissue damage (le-
sions) to the mucosal wall of the intestine.
Toxin B is a highly potent cytotoxin, with
as little as 1 pg of the toxin causing round-
ing of tissue culture cells (9). The toxins
are very unstable, even at refrigerator tem-
peratures and in the frozen state. Several
immunologic tests are available to detect
the toxin, using antibody to the toxin. Cul-
ture for the organism is very sensitive but
not specific, since it detects colonization
with the organism, even when no toxin is
produced (5). In addition, it takes several
days for a positive result. Hence, it is used
only to collect isolates for an epidemio-
logic investigation (see procedure 3.8.1
for culture methods). A latex agglutination
test detects glutamate dehydrogenase, a
nontoxin protein associated with C. diffi-
cile and other anaerobes that may correlate
with CDAD. This test will yield false-
positive results with non-toxin-producing
isolates of C. difficile, Clostridium botu-
linum, Clostridium sporogenes, Peptos-
treptococcus anaerobius, and Bacteroides
asaccharolyticus (10).
The reference method for laboratory
diagnosis of CDAD has been detection of
toxin B by cytotoxin (tissue culture) assay.
Yet the sensitivity of this “gold standard”
method has recently been reevaluated, and
in some studies, it is reported to be about
85 to 90% (15) compared to cytotoxin as-
say of broth cultures from the organism
isolated from anaerobic fecal cultures on
prereduced selective medium (procedure
3.8.1). EIAs, for either toxin A or toxins
A and B are less sensitive than tissue cul-
ture cytotoxicity (generally 70 to 82% sen-
sitive [13, 15]) but may be more practical,
because of their rapid turnaround time and
the instability of the toxins, especially if a
tissue culture assay must be sent to a ref-
erence laboratory. Many commercial tests
detect toxin A, which is present in greater
concentration. Some also detect toxin B,
and a third type detects toxin A and glu-
tamate dehydrogenase (Triage; Biosite Di-
agnostics, San Diego, CA). Tests that de-
tect only toxin A may miss some isolates
that produce toxin B only (2, 11). How-
ever, since toxin B is present in lower
quantities, tests that detect both toxin A
and toxin B may still not be able to detect
low levels of toxin B in stool specimens
and may not have much advantage over
those tests that detect only toxin A. The
Triage is less likely to miss a positive and
has a reported sensitivity of 97.5% (pack-
age insert) to 89% compared to cytotoxin
assay (15). However, the specificity of the
test is 89%. Thus, those results that are
toxin A negative and glutamate dehydro-
genase positive should be confirmed by a
toxin B assay or reported with a qualifi-
cation that they may not be positive for the
toxin (8). Since procedural methods for
the immunologic tests are available in the
package inserts and the options, sensitivi-
ties, and specificities are discussed else-
where (1, 15), this procedure presents only
the cytotoxin assay. However, the speci-](https://image.slidesharecdn.com/microbiologyhandbook-150627125246-lva1-app6892/85/Microbiology-handbook-250-320.jpg)








![H. pylori Cultures 3.8.4.3
C. Urea direct tests
1. Examine each lot visually to determine that no reaction has occurred and
that the test is yellow or straw colored.
2. Prior to each use, make sure there are no signs of contamination or deteri-
oration, (shrinking, cracking, or discoloration) and that the tube is yellow.
Discard any defective tubes and obtain a new one.
3. Check each lot prior to putting it into use with a positively and negatively
reacting organism.
Test organism Result
Proteus mirabilis ATCC 12453 Positive; color change from the original yellow
to pink-red, slower reaction time than
H. pylori
Escherichia coli ATCC 25922 Negative; no color change observed
4. For proficiency, QC, and validation of direct urease test, obtain urease tablets
(Kimberly Clark, Draper, UT). As a positive patient control, insert the tablet
into a negative test, as you would a biopsy sample. After 5 min, inspect for
a positive color change. If the test remains negative, take corrective action.
V. PROCEDURE A. Inoculation
1. Gently homogenize the tissue (refer to procedure 3.13.1 for details on grind-
ing).
ᮃ NOTE: This method of processing results in heavier yields of organisms
compared to either mincing the specimen or direct plating of the specimen.
2. Place several pieces of biopsy material into one of the urea test media and
incubate at 35ЊC under aerobic conditions.
3. Inoculate plate media and immediately incubate under strict microaerophilic
conditions at 35ЊC. When using an airtight jar, add a moistened gauze pad
in the bottom. Use of the Anoxomat system (MART Microbiology) may
improve the yield from H. pylori cultures, since the proper atmospheric con-
ditions are immediately established (http://www.anoxomat.com).
4. Inoculate additional CHOC plate at 35ЊC under aerobic conditions in 5%
CO2.
B. Direct tests
1. Examine the urea test for a pink to magenta color change at 30 min, 4 h,
and 24 h, depending on the manufacturer’s instructions for incubation and
reading.
2. Gram stain and examine for gull wing-shaped, gram-negative rods.
C. Culture methods (also see Campylobacter procedure [3.8.2])
1. Incubate plates at 35 to 37ЊC for 3 to 5 days. Some strains require as long
as 7 days for growth on primary isolation.
2. Examination of culture media
a. Colonies of H. pylori appear as small, gray, and translucent. Some strains
demonstrate weak beta-hemolysis with growth on the microaerobic plates
but not on the aerobically incubated plate.
b. Gram stain suspicious colonies. H. pylori organisms from solid media
appear as slightly curved gram-negative rods.
c. Perform oxidase, catalase, and urea tests from colonies. H. pylori is posi-
tive in all three tests.
IV. QUALITY CONTROL
(continued)
Observe standard precautions.](https://image.slidesharecdn.com/microbiologyhandbook-150627125246-lva1-app6892/85/Microbiology-handbook-259-320.jpg)








![3.9.1.1
3.9 Genital Cultures
3.9.1 Guidelines for Performance of
Genital Cultures
P R E A N A L Y T I C A L C O N S I D E R A T I O N S
I. PRINCIPLE
Specimens from genital sites are sent to
the clinical microbiology laboratory for
detection of microorganisms from females
presenting with clinical syndromes such as
cervicitis, vulvovaginitis, urethritis, bac-
terial vaginosis (BV), salpingitis (pelvic
inflammatory disease [PID]), endometri-
tis, or genital ulcers and from males ex-
hibiting urethritis, epididymitis, prostati-
tis, or genital ulcers (Tables 3.9.1–1 to
3.9.1–3) (3). Specimens are also submitted
from pregnant females to diagnose the
presence of organisms that may cause dis-
ease in the neonate. Less commonly, spec-
imens are sent from children and post-
menopausal women (16, 17, 22, 25, 26).
The syndromes that are associated with
female and male genital tract infections
are listed in Tables 3.9.1–1 to 3.9.1–3,
with the major pathogens for each syn-
drome indicated. For surgically collected
specimens and those from normally sterile
sites, a routine wound and abscess culture
will detect most bacterial pathogens, as
long as selective media for Neisseria gon-
orrhoeae are included. Anaerobic cultures
are often indicated for these specimens
(14), and mycoplasma cultures may be ap-
propriate in selected cases (procedure
3.15).
The human vagina is lined with 25 lay-
ers of epithelium cells. Many indigenous
microorganisms colonize these surfaces.
Accurate diagnosis of genital infections
from the male and female genitalia de-
pends on the separation of microbial path-
ogens from the normal genital microbiota.
The microorganisms colonizing the fe-
male genital tract have been studied exten-
sively and include lactobacilli, Coryne-
bacterium spp., Gardnerella vaginalis,
coagulase-negative staphylococci, Staphy-
lococcus aureus, Streptococcus agalac-
tiae, Enterococcus spp., Escherichia coli,
anaerobes, and yeasts (19). For prepubes-
cent females, diphtheroids and coagulase-
negative staphylococci predominate; lac-
tobacilli predominate in the adult female.
Postmenopausal women are generally col-
onized with fewer lactobacilli but have a
greater number of Enterobacteriaceae
than premenopausal women. They also
lack the presence of yeasts and mycoplas-
mas. Many adult female genital tract in-
fections arise from endogenous microor-
ganisms, the pathogenicity of which has
been activated by host factors and other
microorganisms. Various viruses, includ-
ing herpes simplex virus (HSV), human
papillomavirus (HPV), and human im-
munodeficiency virus, may also influence
the receptivity of the host surface to mi-
croorganisms. The male urethra normally
contains relatively few skin microbiota,
consisting of coagulase-negative staphy-
lococci, micrococci, Corynebacterium
spp., and viridans group streptococci.
Because the agents of disease have di-
verse culture and detection requirements
and selective media are often needed, a
“routine” genital culture, with the intent
to “detect what is there,” rarely has an
indication. Occasionally such specimens
are appropriate for prepubescent or post-
menopausal women. Otherwise, laborato-
ries should provide a special requisition,
such as in Appendix 3.9.1–1, to be used to
request the appropriate tests in the outpa-
tient setting. For certain pathogens, such
as N. gonorrhoeae, Haemophilus ducreyi,
or S. agalactiae (group B streptococcus
[GBS]), cultures are ordered specifically
for those pathogens, with proper collec-
tion and selection media. Because of the
special nature of cultures for these patho-
gens, procedures to detect them are listed
separately in this handbook following this
procedure.
To diagnose vulvovaginitis and BV,
routine bacterial cultures are not helpful
(1, 27). In Table 3.9.1–4, the recom-
mended tests are indicated to make these
diagnoses. Vaginitis is caused by BV, Tri-
chomonas vaginalis, or an overgrowth of
yeasts, typically Candida albicans. Many
laboratories still rely on the Gram stain us-
ing the Nugent scoring system to diagnose
BV (21) (Appendix 3.2.1–3) and to deter-
mine if there is an overgrowth of yeasts.
Rapid tests that detect a high level of sial-
idase produced by organisms associated
with BV are also available and have a sen-
sitivity comparable to that of microscopic
examination. A yeast culture may also be
done if there is a history of recurrent vag-
initis or treatment failure. Wet-mount ex-
amination for detection of T. vaginalis has
a low sensitivity, particularly when spec-
imens are delayed in transit. It should be
noted that performing only a wet mount
without Trichomonas culture may miss
50% of cases (3). Non-culture-based
methods are increasingly being used to
improve detection of T. vaginalis, since
culture requires the maintenance of spe-
cialized media and may also have de-
creased sensitivity when specimens are
delayed in transit (Appendix 9.9.4). Tri-
chomonas rapid antigen and nucleic acid
amplification tests (NAT) are available
and have greater sensitivity for detecting
infection (5, 18). A sensitive DNA probe
assay is also available that combines the](https://image.slidesharecdn.com/microbiologyhandbook-150627125246-lva1-app6892/85/Microbiology-handbook-268-320.jpg)


![Guidelines for Performance of Genital Cultures 3.9.1.4
Table 3.9.1–3 Male genital infections
Clinical syndrome
Location of
infection
Clinical symptoms and signs Primary pathogen(s) Specimen(s) collected
Balanoposthitis Head of penis and
foreskin
Pain, swelling, exudates and
pus under foreskin
Enteric bacteria (e.g., Escheri-
chia coli and other Entero-
bacteriaceae) plus anaer-
obes
Streptococcus pyogenes
Staphylococcus aureus
Swab from under foreskin
Epididymitis Epididymus Pain, swelling, tenderness of
scrotum and epididymus
Chlamydia trachomatis
Enteric bacteria (e.g., Escheri-
chia coli and other Entero-
bacteriaceae, Enterococcus
spp., Pseudomonas spp.)
Mycobacterium tuberculosis
Neisseria gonorrhoeae
Urethral swab
Urine culture
Epididymus tissue
Orchitis Testes Pain, swelling, tenderness of
scrotum
Chlamydia trachomatis
Enteric bacteria (e.g., Escheri-
chia coli and other Entero-
bacteriaceae, Enterococcus
spp., Pseudomonas spp.)
Mycobacterium tuberculosis
Neisseria gonorrhoeae
Urethral swab
Urine culture
Testicular tissue
Prostatic abscess Prostate gland Dysuria, frequency, decreased
urinary stream or obstruc-
tion, passing air on urination
if vesiculoenteric fistula
Enteric bacteria (e.g., Escheri-
chia coli and other Entero-
bacteriaceae, Enterococcus
spp., Pseudomonas spp.)
Staphylococcus aureus
Swab abscess
Abscess fluid/pus
Prostatitis Prostate gland Dysuria, frequency, decreased
urinary stream or obstruc-
tion
Enteric bacteria (e.g., Escheri-
chia coli and other Entero-
bacteriaceae, Enterococcus
spp., Pseudomonas spp.)
Neisseria gonorrhoeae
Urine culturea
Urethral swab
Prostatic fluid
Urethritis Urethra Dysuria, mucopurulent dis-
charge, urethral Gram stain
shows Ͼ4 PMNs/per oil im-
mersion field
Chlamydia trachomatis
Neisseria gonorrhoeae
HSV
Mycoplasma genitalium
Ureaplasma urealyticum
Trichomonas vaginalis
Urethral swab
DFAb
/viral culture
Wet mount of urethral se-
cretions
a
See Table 3.9.1–6 and Appendix 3.9.1–2.
b
DFA, direct fluorescent antibody.
tools in the evaluation of sexually trans-
mitted diseases.
For the recognition of toxic shock syn-
drome (TSS), isolation of S. aureus is dif-
ficult and not sufficient for the diagnosis.
Further characterization of the strain is
necessary to confirm the diagnosis. Two
commercial kits are available for testing,
which is usually done in reference labo-
ratories (Toxic Shock ELISA [Toxin
Technologies, Inc., Madison, WI] and
TST-RPLA reverse passive latex aggluti-
nation [Oxoid, Columbia, MD]). Alterna-
tively, testing acute- and convalescent-
phase sera for antibodies to the exotoxin
(TSST-1) in a reference laboratory can be
helpful. Most patients with TSS lack an-
tibodies at the onset of infection but then
produce them in response to the infection.
Greater than 90% of women have antibod-
ies to the exotoxin.](https://image.slidesharecdn.com/microbiologyhandbook-150627125246-lva1-app6892/85/Microbiology-handbook-271-320.jpg)
![3.9.1.5 Aerobic Bacteriology
A. Specimen collection (see Tables 3.9.1–4 and 3.9.1–5 and Appendix 3.9.1–1 for
options for outpatient testing)
1. Female specimens
a. Amniotic fluid
(1) Aspirate fluid by catheter at cesarean section or at amniocentesis.
(2) Order body fluid culture (procedure 3.5).
b. Bartholin cyst
(1) Decontaminate the skin with povidone-iodine, 3% chloroxylenol, and
3% cocamidopropyl PG-dimonium chloride phosphate (Techni-Care,
Care-Tech, St. Louis, MO) or other surgical disinfectant, and aspirate
material from the duct(s).
ᮃ NOTE: Bartholin glands are small mucus-secreting glands located
beneath the posterior portion of the labia majora.
(2) Order aerobic and anaerobic wound/abscess cultures (procedure
3.13.1).
c. Cervical
(1) Clear away vaginal mucus and exudate with large swab. Moisten
speculum with warm water, not lubricants, which can be antibacterial.
Using a small swab (not cotton or wood shaft) inserted through a
speculum, sample endocervical canal. Avoid the vaginal walls during
collection.
(2) See Table 3.9.1–4 for ordering options.
d. Culdocentesis
(1) After cleaning the vaginal wall with surgical disinfectant, such as
povidone-iodine or 3% chloroxylenol and 3% cocamidopropyl PG-
dimonium chloride phosphate, perform transvaginal puncture of the
cul-de-sac to aspirate fluid.
ᮃ NOTE: The cul-de-sac is the pouch between the anterior wall of
the rectum and the posterior wall of the uterus. Collection is often
done to diagnose PID without more invasive laparoscopy; however,
results may not correlate with more invasive testing.
Observe standard precautions.
Table 3.9.1–4 Diagnostic characteristics for vaginitis and vaginosisa
Disease or
condition
pH
Observation on
wet mount
Amine odorb
Other test(s) for diagnosisc
None (normal) 4–4.5 Long rod form bacteria Absent
Atrophic Ͼ6 Absent
Candidiasis 4–4.5 Pseudohyphae or
budding yeasts
Absent Yeast culture
BV Ͼ4.5 Clue cells Present Gram stain (Nugent’s criteria)
OSOM BV Blue test (Genzyme)
Trichomoniasis 5–6 Flagellated parasitesd
Usually present Trichomonas culture
Rapid antigen test (OSOM Trich [Genzyme])
Nucleic acid amplification test (APTIMA TV [Gen-Probe])
a
Data for table extrapolated from Sobel (27).
b
A drop of 10% KOH is added to vaginal fluid and sniffed for release of fishy or amine odor.
c
These tests are recommended for increased sensitivity and might be offered as a panel by laboratory.
d
Caution: occasional contaminants from the environment, such as Colpoda, while ameboid in motion, may be seen.
ᮃ NOTE: Refer to procedure 3.3.1 for additional details. The following can be
copied for preparation of a specimen collection instruction manual for physicians
and other caregivers. It is the responsibility of the laboratory director or designee
to educate physicians and caregivers on proper specimen collection. In many cases
the procedures to collect the specimens listed below should be performed by qual-
ified physicians with appropriate training.
II. SPECIMEN COLLECTION,
TRANSPORT, AND HANDLING](https://image.slidesharecdn.com/microbiologyhandbook-150627125246-lva1-app6892/85/Microbiology-handbook-272-320.jpg)







![3.9.1.13 Aerobic Bacteriology
hippurate or lipase test reaction than those from patients without BV.
They also showed that the isolation of 3 or 4ם G. vaginalis from culture
correlated well with BV, although 26% of the cases diagnosed by Gram
stain were missed on culture using selective human blood-Tween bilayer
media, which is reported to be superior to V agar (1).
E. Susceptibility testing
1. Antimicrobial susceptibility testing should be performed on all aerobic bac-
terial isolates from pelvic or amniotic fluid or tissue specimens that are con-
sidered to be primary pathogens.
2. Anaerobes isolated from pelvic or amniotic fluid or tissue specimens that are
considered to be primary pathogens should have antimicrobial susceptibility
testing done according to CLSI guidelines (10).
3. N. gonorrhoeae isolated from any genital site should be referred for anti-
microbial susceptibility testing (11).
4. Fastidious gram-negative coccobacilli or rods that do not grow on MAC or
EMB should have a beta-lactamase test.
F. Hold positive culture plates for at least 7 days should further testing be indicated.
V. PROCEDURE (continued)
P O S T A N A L Y T I C A L C O N S I D E R A T I O N S
VI. REPORTING RESULTS A. From surgical specimens and those from normally sterile sites, report the path-
ogens isolated. For cultures with mixed microbiotas, grouping of pathogens may
be indicated, e.g., “Mixed enteric rods or mixed anaerobes present.”
B. If no pathogens are isolated but normal microbiota is present, report as “Normal
genital microbiota isolated” for vaginal and cervical specimens and as “Normal
cutaneous microbiota isolated” for male urethral specimens.
1. See item I of this procedure for list of organisms in the normal microbiota
of male and female genitalia.
2. Do not list genera and species of normal microbiota individually.
3. If specific pathogens are requested, report “No [pathogen name] isolated.”
C. Positive reporting
1. Quantitate pathogens (Table 3.3.2–2).
2. Notify physician of pathogens of serious significance in pregnant females
(e.g., L. monocytogenes) or communicable diseases (e.g., N. gonorrhoeae).
3. Notify the local health department of isolation of agents of reportable dis-
eases.
VII. INTERPRETATION A. The presence of any microorganism from a normally sterile site is generally
considered significant.
B. Isolation of sexually transmitted disease pathogens (e.g., N. gonorrhoeae and
H. ducreyi) is considered clinically significant from any genital site. Isolation
of certain organisms such as S. pyogenes and Clostridium perfringens from soft
tissue as well as endometrial tissue or transvaginal fluid samples should also be
considered clinically significant.
C. The presence of other pathogens may or may not be a cause of disease and must
be evaluated with consideration of relative amounts and symptoms or other
conditions (e.g., pregnancy) in the patient.
D. Due to the increasing resistance of many primary pathogens to commonly used
agents, antimicrobial susceptibility testing may have to be performed on clini-
cally significant aerobic and anaerobic isolates as outlined under item V.E.](https://image.slidesharecdn.com/microbiologyhandbook-150627125246-lva1-app6892/85/Microbiology-handbook-280-320.jpg)














![N. gonorrhoeae Cultures 3.9.3.4
III. MATERIALS A. Media
ᮃ NOTE: For maximum recovery,
culture media for isolation of N. gon-
orrhoeae should include both selective
and nonselective agar formulations ca-
pable of supporting the growth of the
organism. Selective media are de-
signed to prevent overgrowth of con-
taminating normal microbiota. The ad-
dition of a nonselective medium such
as CHOC allows for the growth of a
small percentage of gonococci (ap-
proximately 2%) that are inhibited in
the presence of vancomycin at concen-
trations of 4 lg/ml. Formulations such
as GC-Lect reduce the concentration
of vancomycin to 2 lg/ml (4, 14, 16,
17, 23, 25, 26). In selective medium
formulations, anisomycin has a longer
shelf life than nystatin to inhibit Can-
dida. Trimethoprim is added to inhibit
the growth of Proteus species. (For
vendor information, see procedure
3.1.)
1. CHOC (omit for nasopharyngeal
and rectal sites)
2. One of the following selective me-
dia
a. Modified Thayer-Martin me-
dium (contains vancomycin, co-
listin, nystatin, and trimetho-
prim) is available from most
medium manufacturers.
b. Martin-Lewis medium (contains
vancomycin, colistin, and ani-
somycin) is available from most
medium manufacturers. The
vancomycin concentration is
higher (400 lg/100 ml) in Mar-
tin-Lewis than in Thayer-Martin
medium (300 lg/100 ml).
c. Thayer-Martin improved me-
dium (TM improved) (contains
vancomycin, colistin, anisomy-
cin, and trimethoprim [Remel,
Inc.])
d. TM improved without vanco-
mycin, sold as a biplate with
TM improved (Remel, Inc.)
e. Martin-Lewis medium with lin-
comycin (Hardy Diagnostics)
f. GC-Lect (contains lincomycin,
vancomycin at 200 lg/100 ml,
colistin, trimethoprim, and am-
photericin B) (BD Diagnostic
Systems)
g. New York City medium with
the same antimicrobial agents as
GC-Lect (BD Diagnostic Sys-
tems)
h. The following media provide
both CO2 generation and the
media in a self-contained sys-
tem that promotes survival of N.
gonorrhoeae during transporta-
tion.
(1) JEMBEC (BD Diagnostic
Systems; Remel, Inc.)
(2) Gono-Pak (BD Diagnostic
Systems; Remel, Inc.)
(3) InTray GC (BioMed Diag-
nostics)
3. Biplate formulations containing
both CHOC and selective agar are
available from several manufactur-
ers.
B. Gram stain reagents (procedure
3.2.1)
C. Direct amplification tests
Refer to reference 20.
D. Identification tests
1. Oxidase reagent (see procedure
3.17.39)
2. 30% Hydrogen peroxide (Sigma,
St. Louis, MO) for superoxol test
(2, 24)
3. Nutritionally basic media, such as
nutrient agar, TSA, or Mueller-
Hinton (MH) agar
4. Neisseria identification systems
a. Carbohydrate utilization assay:
cysteine Trypticase agar (CTA)
base with 1% carbohydrates
(glucose, maltose, lactose, and
sucrose) or carbohydrate degra-
dation media with 20% carbo-
hydrates (Remel, Inc.; see pro-
cedure 3.17.9)
b. Coagglutination
(1) Gonogen (New Horizons
Diagnostics; BBL Microbi-
ology, BD Diagnostic Sys-
tems)
(2) Phadebact GC monoclonal
antibody test (Boule Diag-
nostics AB, Huddinge,
Sweden)
c. Monoclonal antibody assay:
GonoGen II (New Horizons Di-
agnostics; BBL Microbiology,
BD Diagnostic Systems)
d. Substrate utilization
(1) RapID NH, BactiCard Neis-
seria, NET (Remel, Inc.)
(2) Gonochek II (EY Labora-
tories, Inc., San Mateo, CA)
(3) Neisseria Screen (Key Sci-
entific Products, Round
Rock, TX)](https://image.slidesharecdn.com/microbiologyhandbook-150627125246-lva1-app6892/85/Microbiology-handbook-295-320.jpg)



![c. Prior to discarding plates, flood plates with oxidase reagent. If a purple
color colony is observed, immediately subculture to CHOC, since oxidase
reagent is toxic to bacteria.
3. Cultures with growth (see Fig. 3.9.3–1)
a. Examine for typical colonies that are small, translucent, raised, gray, and
mucoid with entire margins. When picked from the agar surface, they
tend to come off as whole colonies.
b. Perform a Gram stain and oxidase test on suspicious colonies. If the Gram
stain shows gram-negative diplococci with flattened adjacent sides or
gram-negative cocci in clusters and the oxidase is positive, the isolate is
presumed to be either a Neisseria sp. or M. catarrhalis.
c. If the specimen is sent for diagnosis of carriage of N. meningitidis, ex-
amine CHOC carefully and identify any oxidase-positive, gram-negative
diplococci. These strains may not grow on selective agar.
d. Confirm identification to the species level. If the isolate is from an extra-
genital site or from a child, perform two confirmatory assays that utilize
distinct identification mechanisms (e.g., monoclonal antibody and car-
bohydrate utilization).
(1) Superoxol test (references 2 and 24 and procedure 3.17.10)
(a) Drop 30% hydrogen peroxide reagent onto colony.
(b) N. gonorrhoeae will give immediate, explosive bubbling.
(c) Other species, except some N. meningitidis and M. catarrhalis
strains, show weak reactions. A positive result should only be
considered presumptive for the identification of N. gonorrhoeae.
(2) Subculture typical colonies to a nutritionally basic medium, such as
nutrient agar, TSA, or MH agar, and to CHOC for proof of viability.
Failure of viable organisms to grow on one of these basic media after
overnight incubation at 35ЊC with growth on CHOC indicates a pre-
sumptive pathogenic Neisseria sp.
D. Culture confirmation
Choose one method as the primary method for use in the laboratory.
1. Growth-dependent carbohydrate degradation (procedure 3.17.9)
a. CTA supplemented with 1% carbohydrates
(1) Inoculate tubes containing glucose, maltose, sucrose, and lactose (o-
nitrophenyl-b-D-galactopyranoside [ONPG] may be substituted for
lactose) and a control tube containing no additional carbohydrate
source.
(2) Incubate at least overnight, depending on inoculum density. N. gon-
orrhoeae produces acid only in glucose.
b. Alternatively, use carbohydrate degradation media with 20% carbohy-
drates.
(1) Use a heavy inoculum and incubate for 1 to 4 h, since the test depends
on the presence of preformed enzyme activity and uses a buffered
low-peptone base with 2% glucose, lactose, and sucrose and 0.3%
maltose (29).
(2) Use the same interpretation as for growth carbohydrate degradation
tests.
2. BBL GonoGen
ᮃ NOTE: BBL GonoGen is a monoclonal antibody-based coagglutination
test for the confirmatory identification of N. gonorrhoeae from culture. The
assay is based on the recognition of a major outer membrane protein (protein
I) of the organism.
N. gonorrhoeae Cultures 3.9.3.8
V. PROCEDURES (continued)
It is imperative that these
cultures be handled in a
biological safety cabinet.](https://image.slidesharecdn.com/microbiologyhandbook-150627125246-lva1-app6892/85/Microbiology-handbook-299-320.jpg)


![h. Read the slide using a fluorescent microscope with a 100ן oil objective.
A positive test will demonstrate apple-green fluorescent diplococci along
with appropriate reactions for the positive and negative control wells.
8. AccuProbe N. gonorrhoeae culture identification test
ᮃ NOTE: The AccuProbe system uses a single-stranded DNA probe with
a chemiluminescent label that recognizes an rRNA sequence of N. gonor-
rhoeae. Following the release of the target RNA, the DNA probe forms a
stable DNA:RNA hybrid. A selection reagent inactivates unhybridized probe
and the labeled DNA:RNA hybrids are detected in a luminometer.
a. Label a sufficient number of probe reagent tubes to test the number of
culture isolates and a positive (N. gonorrhoeae) and negative (N. men-
ingitidis) control.
b. Pipette 50 ll of lysis reagent into all tubes.
c. Transfer a 1-ll loopful of cells or several small colonies (Ͻ48 h old) to
the tubes and twirl the loop to remove the cells.
d. Pipette 50 ll of hybridization buffer into all tubes, and mix by vortexing.
e. Incubate tubes for 15 min at 60ЊC in a water bath or dry-heat block.
f. Remove and cool the tubes. Pipette 300 ll of selection reagent to each
tube and mix by vortexing.
g. Incubate tubes for 5 min at 60ЊC in a water bath or dry-heat block.
h. Cool the tubes to room temperature and read results in the luminometer
within 30 min. Cutoff values for positive and negative signals are estab-
lished by the manufacturer for the type of luminometer used.
ᮃ NOTE: The performance of each confirmatory assay discussed above in
terms of the definitive identification of N. gonorrhoeae varies considerably in
the literature. For example, the reported sensitivity of the fluorescent MicroTrak
N. gonorrhoeae culture confirmation test ranges from 76 to 100%, while the
sensitivity of the AccuProbe N. gonorrhoeae culture identification test has con-
sistently been found to be 100% (3, 5, 11, 18, 19, 27, 30).
Based on these findings, a single negative result produced by any of the
confirmatory tests does not rule out an identification of N. gonorrhoeae. Repeat
testing should be performed on a freshly subcultured isolate in conjunction with
lack of growth on nutrient agar and/or carbohydrate utilization tests (see Table
3.9.3–1). Oxidase-positive, gram-negative diplococci that do not grow on nu-
trient agar but are repeatedly negative by any one assay or are uniformly neg-
ative for carbohydrate utilization should be referred to a reference laboratory
for additional testing or evaluated by another identification method.
ᮃ NOTE: Biochemical and/or enzymatic bacterial identification systems that
contain N. gonorrhoeae in their database but have not been specifically designed
for culture confirmation of N. gonorrhoeae (e.g., API NH [bioMe´rieux], IDS
RapID NH panel [Remel, Inc.], BBL CRYSTAL Neisseria/Haemophilus ID kit
[BD Diagnostic Systems], Vitek NHI card [bioMe´rieux], and Microscan HNID
[Dade Behring]) are reviewed elsewhere (13) but can be useful adjuncts for this
purpose.
3.9.3.11 Aerobic Bacteriology
A. Report the Gram stain results as soon as possible, usually within 1 h of receipt
(procedure 3.2.1).
1. Interpret Gram stain for gram-negative intracellular diplococci.
2. Notify physician if smear is positive.
ᮃ NOTE: In contrast to almost all male urethral discharges with gram-neg-
ative diplococci, such morphotypes in vaginal, cervical, or other specimens
are not diagnostic for N. gonorrhoeae.
P O S T A N A L Y T I C A L C O N S I D E R A T I O N S
VI. REPORTING RESULTS
V. PROCEDURES (continued)](https://image.slidesharecdn.com/microbiologyhandbook-150627125246-lva1-app6892/85/Microbiology-handbook-302-320.jpg)


![20. Jerris, R. C., and C. M. Black. 2002. Chla-
mydia trachomatis, p. 128–200. In A. L. Tru-
ant (ed.), Manual of Commercial Methods in
Microbiology. ASM Press, Washington, DC.
21. Kellogg, J. A., and L. K. Orwig. 1995. Com-
parison of GonoGen, GonoGen II, and
MicroTrak direct fluorescent antibody test
with carbohydrate fermentation for confirma-
tion of culture isolates of Neisseria gonor-
rhoeae. J. Clin. Microbiol. 33:474–476.
22. Olsen, C. C., J. R. Schwebke, W. H. Ben-
jamin, Jr., A. Beverly, and K. B. Waites.
1999. Comparison of direct inoculation and
Copan transport systems for isolation of Neis-
seria gonorrhoeae from endocervical speci-
mens. J. Clin. Microbiol. 37:3583–3585.
23. Reichart, C. A., L. M. Rupkey, W. E. Brady,
and E. W. Hook III. 1989. Comparison of
GC-Lect and modified Thayer-Martin media
for isolation of Neisseria gonorrhoeae. J. Clin.
Microbiol. 27:808–811.
24. Saginur, R., B. Clecner, J. Portnoy, and J.
Mendelson. 1982. Superoxol (catalase) test
for identification of Neisseria gonorrhoeae. J.
Clin. Microbiol. 15:475–477.
25. Sng, E. H., V. S. Rajan, K. L. Yeo, and A.
J. Goh. 1982. The recovery of Neisseria gon-
orrhoeae from clinical specimens: effects of
different temperatures, transport times, and
media. Sex. Transm. Dis. 9:74–78.
N. gonorrhoeae Cultures 3.9.3.14
26. Thayer, J. D., and J. E. Martin. 1966. Im-
proved medium selective for cultivation of N.
gonorrhoeae and N. meningitidis. Public
Health Rep. 81:559–562.
27. Turner, A., K. R. Gough, and A. E. Jeph-
cott. 1995. Comparison of three methods for
culture confirmation of Neisseria gonorrhoeae
strains currently circulating in the UK. J. Clin.
Pathol. 48:919–923.
28. Yajko, D. M., A. Chu, and W. K. Hadley.
1984. Rapid confirmatory identification of
Neisseria gonorrhoeae with lectins and chro-
mogenic substrates. J. Clin. Microbiol.
19:380–382.
29. Yong, D. C. T., and A. Prytula. 1978. Rapid
micro-carbohydrate test for confirmation of
Neisseria gonorrhoeae. J. Clin. Microbiol.
8:643–647.
30. Young, H., and A. Moyes. 1993. Compara-
tive evaluation of AccuProbe culture identifi-
cation test for Neisseria gonorrhoeae and
other rapid methods. J. Clin. Microbiol.
31:1996–1999.
SUPPLEMENTAL READING Centers for Disease Control and Prevention.
2000. Gonorrhea—United States, 1998. MMWR
Morb. Mortal. Wkly. Rep. 49:538–542.
Chapel, T. A., M. Smelter, and R. Dassel. 1976.
The effect of delaying incubation in a CO2-en-
riched environment on gonococci. Health Lab.
Sci. 13:45–48.
Evangelista, A., and H. Beilstein. 1992. Cumi-
tech 4A, Laboratory Diagnosis of Gonorrhea. Co-
ordinating ed., C. Abramson. American Society
for Microbiology, Washington, DC.
Evans, K. D., E. M. Peterson, J. I. Curry, J. R.
Greenwood, and L. M. de la Maza. 1986. Effect
of holding temperature on isolation of Neisseria
gonorrhoeae. J. Clin. Microbiol. 24:1109–1110.
Ingram, D. L., V. D. Everett, L. A. Flick, T. A.
Russell, and S. T. White-Sims. 1997. Vaginal
gonococcal cultures in sexual abuse evaluations:
evaluation of selective criteria for preteenaged
girls. Pediatrics 99:E8.
Iwen, P. C., R. A. Walker, K. L. Warren, D. M.
Kelly, J. Linder, and S. H. Hinrichs. 1996. Ef-
fect of off-site transportation on detection of Neis-
seria gonorrhoeae in endocervical specimens.
Arch. Pathol. Lab. Med. 120:1019–1022.
Koumans, E. H., R. E. Johnson, J. S. Knapp,
and M. E. St. Louis. 1998. Laboratory testing for
Neisseria gonorrhoeae by recently introduced
nonculture tests: a performance review with clini-
cal and public health considerations. Clin. Infect.
Dis. 27:1171–1180.
Palmer, H. M., H. Mallinson, R. L. Wood, and
A. J. Herring. 2003. Evaluation of the specifici-
ties of five DNA amplification methods for the
detection of Neisseria gonorrhoeae. J. Clin. Mi-
crobiol. 41:835–837.
Ratner, J. B., H. Tinsley, R. E. Keller, and C.
W. Stratton. 1985. Comparison of the effect of
refrigerated versus room temperature media on the
isolation of Neisseria gonorrhoeae from genital
specimens. J. Clin. Microbiol. 21:127–128.
Rosey, C. E., and E. M. Britt. 1984. Urine as a
holding medium for Neisseria gonorrhoeae. Sex.
Transm. Dis. 11:301–303.
Shapiro, R. A., C. J. Schubert, and R. M. Siegel.
1999. Neisseria gonorrhea [sic] infections in girls
younger than 12 years of age evaluated for vagi-
nitis. Pediatrics 104:e72.
REFERENCES (continued)](https://image.slidesharecdn.com/microbiologyhandbook-150627125246-lva1-app6892/85/Microbiology-handbook-305-320.jpg)














![3.11.1.1
3.11 Respiratory Tract Cultures
3.11.1 Guidelines for Performance of
Respiratory Tract Cultures
Specimens from the upper respiratory tract
(throat specimens, nasopharyngeal swabs,
nasal discharges) can be easily obtained
but are contaminated with resident micro-
biota. In addition, many microorganisms
present in the nares and throat are found
in both the disease and the carrier states
(2, 3, 4). It is estimated that 60% of chil-
dren sporadically carry Streptococcus
pneumoniae in their nasal passages by the
age of 2 years (2). Because of this contam-
ination, these specimens often do not pro-
vide accurate, clinically useful informa-
tion for diagnosis of bacterial respiratory
infection caused by organisms such as S.
pneumoniae, Haemophilus influenzae, and
Moraxella catarrhalis. On the other hand,
these specimens are useful for the diag-
nosis of specific pathogens, whose pres-
ence in symptomatic patients most often
indicates disease (i.e., Streptococcus py-
ogenes, Bordetella pertussis, Corynebac-
terium diphtheriae, and respiratory vi-
ruses). Nasal cultures are also performed
as a part of the infection control of hos-
pitalized patients to detect carriage of ox-
acillin-resistant Staphylococcus aureus or
as part of a staphylococcal outbreak. In the
latter case, nasal carriage by hospital em-
ployees may also be important (procedure
13.17). However, culture of nasopharyn-
geal specimens to detect carriage of poten-
tial pathogens such as Neisseria meningi-
tidis, S. pneumoniae, and H. influenzae
should be discouraged. Since these path-
ogens are all part of the normal oropha-
ryngeal flora, the clinical relevance of cul-
turing them from this site cannot be
determined. In addition, reporting of nor-
mal oropharyngeal flora from this site may
result in the patient receiving an unnec-
essary course of antibiotic therapy, thus
fostering the development of resistance.
Antibiotic prophylaxis of individuals in
close contact with a patient with menin-
gococcemia should be directed by the
CDC guidelines, and should not be with-
held based on the nasopharyngeal culture
result (1). Likewise, nasopharyngeal spec-
imen cultures for yeast or mold coloniza-
tion in otherwise healthy asymptomatic in-
dividuals should be discouraged for
similar reasons. Nasopharyngeal cultures
for the detection of either Aspergillus spp.,
Mucor spp., or other fungi may be war-
ranted for immunocompromised patients
who are suspected of having an invasive
infection.
Thus, a request for “routine” bacterial
culture of noninvasively collected nasal or
throat specimens, usually submitted to the
laboratory on swabs or as a wash, aspirate,
or discharge, should not be processed by
the laboratory (refer to cystic fibrosis pro-
cedure [3.11.3] for exception for deep
pharyngeal cultures from these patients).
It is important that these cultures be done
only when detection of a specific pathogen
is sought and not be performed routinely
to detect any organism that is present.
When requests are received by the labo-
ratory, the caregiver should be contacted
to determine if the specimen was sent for
detection of one of the specific pathogens
(Table 3.11.1–1). If the specimen is being
sent to diagnose a bacterial cause of lower
respiratory disease, otitis media, or sinus-
itis, inform the caregiver that a more
invasive specimen, such as endotracheal
aspirate, maxillary sinus puncture, or tym-
panocentesis fluid, respectively, is needed
to make the diagnosis (see Table 3.11.1–
1 for specific specimens and procedural
references). Procedures that follow in this
portion present collection, processing, and
interpretation to detect individual respira-
tory pathogens and procedures for bacte-
rial etiology of upper and lower respira-
tory disease from specific anatomic sites.
A procedure is also listed specifically for
processing specimens from cystic fibrosis
patients. Refer to Table 3.11.1–1 for the
appropriate specimens and procedures.
REFERENCES 1. Bilukha, O. O., and N. Rosenstein. 2005.
Prevention and control of meningococcal dis-
ease. Recommendations of the Advisory Com-
mittee on Immunization Practices (ACIP).
MMWR Morb. Mortal. Wkly. Rep. 54(RR-
7):1–21.
2. Dagan, R., R. Melamed, M. Muallem, L.
Piglansky, and P. Yagupsky. 1996. Nasopha-
ryngeal colonization in southern Israel with
antibiotic-resistant pneumococci during the
first 2 years of life: relation to serotypes likely
to be included in pneumococcal conjugate
vaccines. J. Infect. Dis. 174:1352–1355.
3. Faden, H., M. Heimerl, G. Goodman, P.
Winkelstein, and C. Varma. 2002. New tech-
nique (the NOW test) for rapid detection of
Streptococcus pneumoniae in the nasophar-
ynx. J. Clin. Microbiol. 40:4748–4749.
4. Robinson, D. A., K. M. Edwards, K. B. Wai-
tes, D. E. Briles, M. J. Crain, and S. K. Holl-
ingshead. 2001. Clones of Streptococcus
pneumoniae isolated from nasopharyngeal
carriage and invasive disease in young chil-
dren in central Tennessee. J. Infect. Dis.
183:1501–1507.](https://image.slidesharecdn.com/microbiologyhandbook-150627125246-lva1-app6892/85/Microbiology-handbook-320-320.jpg)















![3.11.2.14 Aerobic Bacteriology
b. For inpatients, regardless of the presence of other pathogens, examine
for significant numbers of Pseudomonas aeruginosa, Acinetobacter,
Burkholderia, and Stenotrophomonas organisms because they are typi-
cally resistant to multiple antimicrobials and can be implicated in nos-
ocomial epidemics.
c. If more than one type of other gram-negative rods are present in equal
numbers, perform minimal testing to be able to describe the organisms
(e.g., indole, oxidase, odor and morphology on MAC, colony pigment,
and reaction on Kligler’s iron agar [KIA] or triple sugar iron agar [TSI]).
d. See procedure 3.11.3 for special requirements for cystic fibrosis patients.
5. Staphylococci
a. Identify S. aureus if present in significant amounts.
(1) Perform AST if the Gram stain shows predominant cocci in clusters
associated with WBCs and no other pathogen in significant amounts.
(2) If the patient is an inpatient, based on infection control policy, check
for resistance to oxacillin, even if organism is present in low num-
bers.
b. Identify coagulase-negative staphylococci, without species identification
or AST, only if they are in 90% pure culture. Otherwise include in
respiratory microbiota.
6. Do not report Enterococcus unless the culture is 90% pure and the identi-
fication is confirmed with extensive biochemical tests. See procedure
3.18.1. Many gram-positive cocci in the normal respiratory tract are PYR
positive and even bile-esculin and LAP (leucine aminopeptidase) positive.
7. Gram-positive rods
a. Rule out Nocardia in any amount and Rhodococcus equi (mucoid and
urease positive) from immunocompromised patients (see procedures 6.1
and 6.2 and Table 3.18.1–6).
b. Examine for large, spore-forming, gram-positive rods. If present, iden-
tify Bacillus anthracis and Bacillus cereus.
c. Limit identification of Corynebacterium, using a commercial kit for
gram-positive rods, to those present in numerous and predominant
amounts and when either of the following is true.
(1) The organism is rapid urea positive. (Corynebacterium pseudodi-
phtheriticum is urea positive.)
(2) The specimen is from an intubated patient from an ICU.
d. Generally, do not pursue other gram-positive rods, as they are unlikely
to cause pneumonia.
8. Identify molds (section 8), unless the organism is consistent with a labo-
ratory or environmental contaminant (e.g., Penicillium).
ᮃ NOTE: Biphasic fungi (Histoplasma capsulatum and Coccidioides im-
mitis) can be isolated from plates held for Ͼ48 h, even as the yeast-phase
colony morphology. Use caution in examination of older cultures.
9. Rule out Cryptococcus (section 8) and do not identify other yeasts further.
ᮃ NOTE: Candida organisms are not a cause of pneumonia, except pos-
sibly in oncology (e.g., leukemia) or lung transplant patients or in neonates.
Even in those cases, growth of Candida in lower respiratory specimens,
regardless of species, does not correlate with disease (4). Yeasts are normal
inhabitants of the mouth.
10. If bacteria were seen on smear but did not grow on culture, extend the
incubation and inoculate other media (e.g., for Legionella, Bordetella per-
tussis, and Mycobacterium).
V. PROCEDURE (continued)
It is imperative that these
cultures be handled in a
biological safety cabinet.](https://image.slidesharecdn.com/microbiologyhandbook-150627125246-lva1-app6892/85/Microbiology-handbook-336-320.jpg)
![Lower Respiratory Tract Cultures 3.11.2.15
P O S T A N A L Y T I C A L C O N S I D E R A T I O N S
VI. REPORTING RESULTS A. Report the presence of cells and bacteria from Gram stains of lower respiratory
specimens as outlined in procedure 3.2.1. If significant bacterial morphotypes
are found in the Gram stain, which do not grow in culture, a comment about
this discrepancy should be provided on the report.
B. Report “No growth of pathogens or normal upper respiratory tract microorgan-
isms” if there is no growth on any plates.
ᮃ NOTE: This may be indicative of antimicrobial inhibition of normal micro-
biota.
C. Positive reporting
1. Report preliminary and final results as “Isolates consistent with microorgan-
isms encountered in the upper respiratory tract” if no pathogens are isolated.
2. Report all pathogens and susceptibility tests performed using Table 3.11.2–
1 as a guide.
3. Provide preliminary reports as indicated in procedure 3.3.2.
4. Report AST in accordance with CLSI guidelines (3) and section 5.
VII. INTERPRETATION A. A positive culture with S. pneumoniae or H. influenzae generally indicates in-
fection with that organism, although carriage of these organisms may lead to
false-positive results.
B. A positive culture with a predominant gram-negative rod or S. aureus generally
indicates infection with that agent if the smear suggests an infectious process
involving the corresponding morphology.
C. A negative bacterial culture does not rule out lower respiratory infection. The
primary pathogen is frequently not recovered from patients with pneumonia,
either because they have already been started on antimicrobial therapy when
samples are taken or because they have infection with another type of organism
(e.g., virus, parasite, fungus, mycoplasma, or mycobacterium) that will not be
recovered by bacterial culture.
D. Although published guidelines by several expert groups are controversial about
the clinical utility of sputum bacterial cultures for the diagnosis of CAP (6),
lower respiratory tract specimens should be collected and analyzed to determine
the microbial cause of infection in patients with nosocomial pneumonia or VAP.
E. CAP guidelines recommend treatment of ambulatory patients with either amox-
icillin or amoxicillin-clavulanate or a macrolide. A fluoroquinolone with en-
hanced activity against penicillin-resistant strains of S. pneumoniae (i.e., levo-
floxacin [Levaquin]) should be used in patients with CAP, particularly those
with severe infection who require admission to a hospital (2, 6).
F. Bacterial isolates from patients with nosocomial pneumonia and VAP are more
likely to have resistance to one of the more commonly used agents. Primary
bacterial pathogens should have AST reported to direct appropriate therapy.
G. Immunocompromised patients with progressive pneumonia are more likely to
have infection due to Legionella or a nonbacterial cause of infection. Lower
respiratory tract specimens (i.e., BAL and/or OLB specimens) should be col-
lected early in the course of the infection in order to optimize the recovery of
unusual pneumonia pathogens, including Legionella, P. jiroveci (formerly
P. carinii), viruses, fungi, mycoplasmas, and mycobacteria. Laboratories should
refer to the specific sections of this handbook that provide detailed procedures
for the analysis of clinical specimens to detect these pathogens.](https://image.slidesharecdn.com/microbiologyhandbook-150627125246-lva1-app6892/85/Microbiology-handbook-337-320.jpg)

![Lower Respiratory Tract Cultures 3.11.2.17
SUPPLEMENTAL READING Carroll, K. C. 2002. Laboratory diagnosis of
lower respiratory tract infections: controversy and
conundrums. J. Clin. Microbiol. 40:3115–3120.
Centers for Disease Control and Prevention.
2000. Preventing pneumococcal disease among
infants and young children: recommendations of
the Advisory Committee on Immunization Prac-
tices (ACIP). MMWR Morb. Mortal. Wkly. Rep.
49(RR-9):1–35.
Sharp, S. E., A. Robinson, M. Saubolle, M.
Santa Cruz, K. Carroll, and B. Baselski. 2003.
Cumitech 7B, Lower Respiratory Tract Infections.
Coordinating ed., S. E. Sharp. American Society
for Microbiology, Washington, DC.
APPENDIX 3.11.2–1 Quantitative Culture of Protected Specimen Brush and Bronchoalveolar
Lavage Fluid Specimens
P R E A N A L Y T I C A L C O N S I D E R A T I O N S
I. PRINCIPLE
Quantitative cultures increase the specificity of the diagnosis, but the sensitivity is
dependent on the threshold chosen for a positive result. Many authors report a colony
count of Ն104
CFU/ml to be consistent with bacterial pneumonia, whereas counts below
104
CFU/ml likely indicate contamination with oronasal microbiota (1, 2, 5–7). This
theory has been validated in numerous clinical studies, and quantitative culture of BAL
fluid specimens has become the reference method for the diagnosis of pneumonia by
BAL (3). For PBS, a colony count of Ն103
CFU/ml is consistent with bacterial pneu-
monia. Taking the dilution factor of both specimen effluents into consideration, this
represents a count of bacteria in the secretions of the lung of 105
to 106
CFU/ml (2).
There are two methods of performing quantitative cultures: the serial dilution method
and the calibrated-loop method (1, 2). After incubation the colonies are counted and
multiplied by the appropriate dilution factor to determine the number of bacteria present
in 1 ml of fluid.
II. MATERIALS
A. Primary media
1. BAP or
2. CHOC
B. Other supplies/equipment
1. Pipette method
a. One 100-ll pipettor with sterile tips
b. Two 16- by 125-mm snap-cap tubes containing 5 ml of sterile phosphate-
buffered saline or suitable broth
2. Loop method
a. 0.001-ml (1-ll)
b. 0.01-ml (10-ll) loop
c. Disposable loops are color coded according to volume delivery.
3. Sterile bent glass or plastic disposable sterile rods (hockey sticks) to spread
inoculum (Excel Scientific, Wrightwood, CA, [760] 249-6371).
4. Petri dish turntable to rotate plates (optional)
5. Incubator at 35ЊC with 5% CO2 or other CO2-generating system
A N A L Y T I C A L C O N S I D E R A T I O N S
III. QUALITY CONTROL
A. For calibrated-pipette QC, refer to Appendix 3.12–4. If calibrated loops are used,
verify that they are accurate by one of the methods in Appendix 3.12–3.
ᮃ NOTE: Jacobs et al. (4) have indicated that actual BAL fluid should be used to
validate the accuracy of the loops. Some, but not all, loops provide accurate results.
B. Refer to procedure 3.11.2 for medium QC testing.
IV. PROCEDURES
A. Inoculation (see Fig. 3.11.2–A1).
1. Vortex specimen vial vigorously for 30 to 60 s.
2. Label a BAP or CHOC for each dilution. Do not use selective medium. If CHOC
contains bacitracin, use BAP. Otherwise use CHOC for quantitative culture. In-
oculate other media according to procedure 3.11.2 for other lower respiratory
tract pathogens.
Observe standard precautions.
It is imperative that these
cultures be handled in a
biological safety cabinet.](https://image.slidesharecdn.com/microbiologyhandbook-150627125246-lva1-app6892/85/Microbiology-handbook-339-320.jpg)





![Respiratory Cultures from Cystic Fibrosis Patients 3.11.3.3
III. MATERIALS A. Media for culture
1. CHOC or horse blood agar with or
without 20,000 U of bacitracin per
liter (6) for recovery of H. influen-
zae (Remel, Inc.; BD Diagnostic
Systems)
ᮃ NOTE: The addition of bacitra-
cin will inhibit most strains of
streptococci, staphylococci, and
Neisseria and Micrococcus species,
but Escherichia coli, some Neis-
seria species, and strains of Can-
dida, Klebsiella, Proteus, and
Pseudomonas spp. as well as other
bacteria may grow on the medium.
2. Mannitol salt agar (MSA) for re-
covery of S. aureus
3. MAC
4. Columbia colistin-nalidixic acid
agar (CNA)
5. B. cepacia selective agar (BCSA)
(Remel, Inc.; Hardy Diagnostics)
(11)
ᮃ NOTE: This medium contains
lactose and sucrose with phenol red
and crystal violet to differentiate
colonies that oxidize these carbo-
hydrates from those that do not, as
well as polymyxin B, gentamicin,
and vancomycin to inhibit most
other bacteria.
B. Biochemical tests
1. See procedures 3.3.2 and 3.18.2 for
standard laboratory tests and flow-
charts helpful in identification of
organisms recovered from CF pa-
tients.
2. For nonfermenting, gram-negative
rods, use a commercial kit designed
to identify them (e.g., Vitek GNI,
GNI Plus, or API 20NE [bio-
Me´rieux, Inc.]; RapID NF Plus or
N/F System [Remel, Inc.]; Micros-
can GNP [Dade-Behring Micros-
can]; Crystal E/NF [BD Diagnostic
Systems]). Refer to procedure 3.1
for vendor contact information.
3. In addition, the following tests are
helpful.
a. Lysine and ornithine decarbox-
ylase (procedure 3.17.15)
b. o-Nitrophenyl-b-D-galactopy-
ranoside (ONPG) (procedure
3.17.37)
c. OF sugars (glucose, lactose,
maltose, mannitol, adonitol, su-
crose, and xylose [procedure
3.17.9])
d. Colistin or polymyxin B disks
(procedure 3.17.4)
e. DNase (procedure 3.17.16)
4. Etests (AB Biodisk, Solna, Swe-
den) for trimethoprim-sulfa-
methoxazole, ticarcillin-clavulanic
acid, and ceftazidime for suscepti-
bility testing of S. maltophilia
5. Antimicrobial disks for susceptibil-
ity testing (procedure 5.1) or micro-
dilution MIC method with over-
night incubation (procedure 5.2)
A N A L Y T I C A L C O N S I D E R A T I O N S
IV. QUALITY CONTROL A. Verify that media meet expiration date and QC parameters per Clinical and
Laboratory Standards Institute (CLSI; formerly NCCLS) document M22-A3
(4). See procedures 14.2 and 3.3.1 for further procedures, especially for in-
house-prepared media.
B. QC the following media by lot when received.
1. Haemophilus media with bacitracin (see procedure 3.11.2 for details)
2. CHOC (see procedure 3.2.1 for details)
3. BCSA
Incubation
Test organism
Time (h) Temp (ЊC) Atmosphere
Result
B. cepacia ATCC 25416 24–72 35 Aerobic Growth
P. aeruginosa ATCC 27853 24 35 Aerobic Partial to complete
inhibition
S. aureus ATCC 25923 24 35 Aerobic Partial to complete
inhibition](https://image.slidesharecdn.com/microbiologyhandbook-150627125246-lva1-app6892/85/Microbiology-handbook-345-320.jpg)